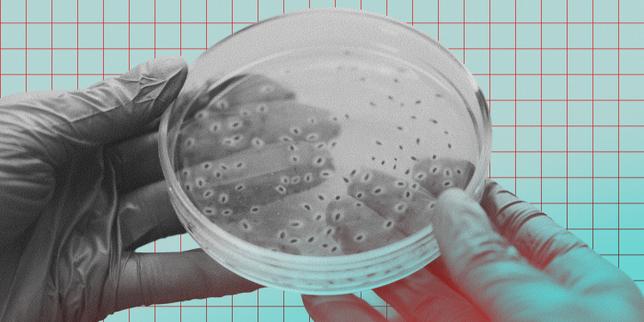

Recherche Partagé
Citation du jour:
Si vous fermez la porte à tous les échecs, le succès restera dehors.
Calculatrice Outils Vidéos Vidéos Youtube Radios Images Codes Plus de Codes
Radio en Ligne
Recherche Partagé
Citation du jour:
Si vous fermez la porte à tous les échecs, le succès restera dehors.
Calculatrice Outils Vidéos Vidéos Youtube Radios Images Codes Plus de Codes
Radio en Ligne


Une pointe d’humour: C'est samedi, c’est Bob
And the winner is Nicolas Walder, qui prend un poste qu’on ne conseillerait pas à son pire ennemi! Mais il est content, alors tant mieux.🕒 08:04 · 25 / 10 / 2025 | 📰 Source : partner-feeds.publishing.tamedia.ch


Un Genevois passe à la caisse: Un chantier souille ses abricots: il reçoit 180’000 francs
En 2015, un arboriculteur valaisan a vu 42 tonnes de sa récolte d’abricots être souillées par la poussière d’un chantier. Dix ans plus tard, il est dédommagé.🕒 11:21 · 23 / 10 / 2025 | 📰 Source : partner-feeds.publishing.tamedia.ch


Commerce en ligne: Les Suisses achètent sur Temu ou Shein, mais ils ont des remords
Une étude montre que la population suisse fait régulièrement des achats sur des sites chinois à bas coûts tout en connaissant les méfaits de ces plateformes.🕒 11:02 · 23 / 10 / 2025 | 📰 Source : partner-feeds.publishing.tamedia.ch


Dessins de presse: Chappatte et Ann Telnaes croquent l’Amérique de Trump dans un album
Le dessinateur genevois et sa consœur américaine croisent leurs mots et leurs dessins dans un magnifique livre sur la censure aux États-Unis.🕒 11:01 · 23 / 10 / 2025 | 📰 Source : partner-feeds.publishing.tamedia.ch


Constructeur automobile en difficulté: Le bénéfice net de Tesla chute au 3e trimestre
Le géant californien des voitures électriques voit son bénéfice fondre comme neige au soleil. Pendant que les ventes progressent, les coûts explosent et les investisseurs s’inquiètent.🕒 10:58 · 23 / 10 / 2025 | 📰 Source : partner-feeds.publishing.tamedia.ch


Égalité dans le sport: Les fédérations sportives résistent au quota féminin de Viola Amherd
Viola Amherd voulait féminiser le sport suisse en imposant 40% de femmes aux comités directeurs. Mais les fédérations sportives suisses ignorent encore ce quota.🕒 10:49 · 23 / 10 / 2025 | 📰 Source : partner-feeds.publishing.tamedia.ch


Compétences de base: 15% de la population suisse a des difficultés à lire et à compter
Environ 844’000 Suisses âgés de 16 à 65 ans manquent de compétences essentielles. Ces personnes gagnent moins et participent moins à la vie sociale que la moyenne.🕒 10:43 · 23 / 10 / 2025 | 📰 Source : partner-feeds.publishing.tamedia.ch


Trump menace la Colombie: Les États-Unis frappent des bateaux soupçonnés de narcotrafic
Des bombardements américains ont tué 5 navigateurs dans le Pacifique entre mardi et mercredi, tandis que Trump accuse le président colombien d’être un «baron de la drogue».🕒 10:25 · 23 / 10 / 2025 | 📰 Source : partner-feeds.publishing.tamedia.ch


Successeur d’Urs Lehmann: Peter Barandun est le nouveau président de Swiss-Ski
Le Grison était, depuis juin 2024, coprésident de l’instance avec Urs Lehmann. Il prend désormais seul les rênes après une élection à l’unanimité.🕒 10:16 · 23 / 10 / 2025 | 📰 Source : partner-feeds.publishing.tamedia.ch


Remontées mécaniques en Suisse: Les abonnements de ski vont augmenter de 2 à 5% cet hiver
Les stations suisses appliquent une hausse généralisée des tarifs pour la saison à venir. Les prix dynamiques, qui favorisent les achats anticipés, se généralisent.🕒 10:09 · 23 / 10 / 2025 | 📰 Source : partner-feeds.publishing.tamedia.ch


Sortie prévue le 4 novembre: Coup d’envoi pour les équipes féminines dans le jeu vidéo Football Manager
Après 43 ans d’existence, la franchise culte s’ouvre aux équipes féminines avec 36’000 joueuses. Un pari qui divise encore la communauté, malgré des réactions largement positives.🕒 10:07 · 23 / 10 / 2025 | 📰 Source : partner-feeds.publishing.tamedia.ch


Art contemporain à Genève: Le brodeur Vfelder signe sa première expo
Après les vêtements, le Genevois de 30 ans pousse son art à ses limites et présente «Fil bleu» dans le quartier de Plainpalais.🕒 09:42 · 23 / 10 / 2025 | 📰 Source : partner-feeds.publishing.tamedia.ch


Tempête Benjamin: Des rafales de 131 km/h aux Diablerets et 111 km/h à Nyon
Des vents violents et des fortes précipitations sont attendues ce jeudi en Suisse. Le pic d’intensité devrait être atteint entre 9 h et 15 h.🕒 09:41 · 23 / 10 / 2025 | 📰 Source : partner-feeds.publishing.tamedia.ch


France: «Je vais bien», assure Brigitte Bardot après des rumeurs de décès
L’icône du cinéma français a été annoncée morte par le blogueur Aqababe mercredi. L’actrice et chanteuse a démenti.🕒 09:25 · 23 / 10 / 2025 | 📰 Source : partner-feeds.publishing.tamedia.ch


Village évacué aux Grisons: Beaucoup d’habitants de Brienz veulent être relogés ailleurs
Menacés par un éboulement, de nombreux résidents ont décidé de ne jamais revenir dans le village. C’est plus que le nombre prévu par les autorités de la commune.🕒 09:23 · 23 / 10 / 2025 | 📰 Source : partner-feeds.publishing.tamedia.ch


Projet caritatif: Un Genevois marche autour du Léman pour Gaza
Le jeune homme invite les Romands à l’accompagner dans ce périple. Les fonds récoltés seront versés à l’Association Yaffa, œuvrant pour les enfants en Palestine.🕒 09:12 · 23 / 10 / 2025 | 📰 Source : partner-feeds.publishing.tamedia.ch


Restructuration chez le géant des réseaux sociaux: Meta supprime 600 emplois au sein de sa division IA
Meta réduit ses effectifs dans l’intelligence artificielle après une importante campagne de recrutement. L’objectif est d’accélérer les prises de décisions.🕒 08:47 · 23 / 10 / 2025 | 📰 Source : partner-feeds.publishing.tamedia.ch


Blocage aux États-Unis: Shutdown aux USA: «On devra se serrer la ceinture»
Plus payés depuis le 1er octobre, des centaines de milliers de fonctionnaires sont affectés par la fermeture de l’État fédéral. Le bout du tunnel n’est pas en vue. Témoignage.🕒 08:33 · 23 / 10 / 2025 | 📰 Source : partner-feeds.publishing.tamedia.ch


Fabia Gnädinger à la barre: À Genève, la résistance s’organise pour sauver le club de volley
Fabia Gnädinger, présidente de Genève Volley, raconte les efforts du nouveau comité pour éviter la faillite et évoluer en LNA.🕒 08:00 · 23 / 10 / 2025 | 📰 Source : partner-feeds.publishing.tamedia.ch


La nouvelle vie mouvementée du suspect de l'affaire Maddie
Libéré en septembre, l'Allemand Christian Brückner vit désormais dans la rue, dans le nord de l'Allemagne.🕒 11:19 · 23 / 10 / 2025 | 📰 Source : partner-feeds.20min.ch


Mis en examen à 13 ans après le viol filmé d’un garçon de 9 ans
Un adolescent a été mis en examen après avoir filmé un viol sur un enfant de 9 ans par un autre petit garçon.🕒 11:09 · 23 / 10 / 2025 | 📰 Source : partner-feeds.20min.ch


Une vidéo d’un influenceur gravissant seul le Cervin fait le buzz
Skip Pannatier, guide de montagne à Zermatt, nous fait part de son inquiétude de voir une vidéo de l’ascension du Cervin entrainer des comportements dangereux.🕒 11:00 · 23 / 10 / 2025 | 📰 Source : partner-feeds.20min.ch


Nouvelles règles dans le cadre du transfert de Moutier
Deux nouveaux accords liés au transfert de Moutier ont été signés par les cantons de Berne et du Jura. Le premier, sur la police, entre en vigueur le 15 novembre.🕒 10:32 · 23 / 10 / 2025 | 📰 Source : partner-feeds.20min.ch


Les premières images de la tempête Benjamin
La première tempête automnale de l’année frappe la Suisse avec des vents violents. Une pointe à 131 km/h a été mesurée aux Diablerets. (chs)🕒 10:13 · 23 / 10 / 2025 | 📰 Source : partner-feeds.20min.ch


Revue et Cirque de Noël se disputent la Plaine de Plainpalais
Le spectacle satirique devrait s’installer sur l’espace à partir de 2026. Mais le Cirque a saisi la justice.🕒 10:13 · 23 / 10 / 2025 | 📰 Source : partner-feeds.20min.ch


Poursuivie pour plagiat dans un titre mentionnant Sydney Sweeney
La chanteuse Lizzo est poursuivie devant un tribunal californien pour plagiat. Les faits concernent un extrait d'un titre non publié.🕒 10:11 · 23 / 10 / 2025 | 📰 Source : partner-feeds.20min.ch


Trump manque-t-il vraiment de «courage et d'intégrité»?
Les propos attribués au président du comité Nobel affirmant que «courage et intégrité» manquaient à Donald Trump sont faux. Ils ont été déformés. (fch)🕒 10:01 · 23 / 10 / 2025 | 📰 Source : partner-feeds.20min.ch


«Il était en train de coucher avec ma mère»
En Pennsylvanie, un homme de 55 ans aurait été abattu par le fils de sa nouvelle compagne, furieux de les avoir surpris en plein acte sexuel.🕒 10:00 · 23 / 10 / 2025 | 📰 Source : partner-feeds.20min.ch


Décos de Noël éteintes pendant la nuit: la polémique enfle
Le canton du Valais souhaite lutter contre la pollution lumineuse publique et privée entre minuit et 6h du matin. À peine envisagé, le projet fait déjà des remous.🕒 10:00 · 23 / 10 / 2025 | 📰 Source : partner-feeds.20min.ch


La police de l’immigration de Trump dépense sans compter
Alors que d’autres agences gouvernementales fonctionnent au ralenti en raison de la fermeture partielle de l’administration, l’ICE est largement épargnée.🕒 09:16 · 23 / 10 / 2025 | 📰 Source : partner-feeds.20min.ch


En soins intensifs après des injections illégales de Botox
Des cas graves de botulisme ont été signalés en France après des injections illégales de toxine botulinique, par des personnes «non habilitées».🕒 08:53 · 23 / 10 / 2025 | 📰 Source : partner-feeds.20min.ch


Comment Stan Wawrinka lutte contre le trac en vieillissant
À 40 ans, le Vaudois est souvent très nerveux avant un match. Et cela ne s'arrange pas sous les yeux de ses fans aux Swiss Indoors de Bâle.🕒 08:18 · 23 / 10 / 2025 | 📰 Source : partner-feeds.20min.ch


Les soins capillaires lissants, passeport pour le cancer?
Certains de ces produits contiennent un composé chimique qui fait exploser le risque de cancer du pancréas ou de la thyroïde, alerte une étude américaine.🕒 08:17 · 23 / 10 / 2025 | 📰 Source : partner-feeds.20min.ch


Ligne haute tension au sol, chutes d'arbres: il y a des dégâts
La première tempête automnale frappe la Suisse avec des vents violents. Une pointe à 131 km/h a été mesurée aux Diablerets.🕒 08:15 · 23 / 10 / 2025 | 📰 Source : partner-feeds.20min.ch


Adel des 2be3: «On était trois amis avant d'être un boys band»
La série «Culte–2Be3» sort le 24 octobre sur Prime Video. Membre du trio, Adel Kachermi, qui travaille à Genève dans la conciergerie de luxe, revient sur cette aventure.🕒 08:11 · 23 / 10 / 2025 | 📰 Source : partner-feeds.20min.ch


Il tente tout pour déduire des barres protéinées de ses impôts
Un Bernois qui se rend au travail à vélo s'est battu, en vain, pour pouvoir soustraire de sa déclaration d'impôts près de 3400 fr. de frais liés à son mode de transport.🕒 08:10 · 23 / 10 / 2025 | 📰 Source : partner-feeds.20min.ch


Belinda Bencic en quarts à Tokyo
La Saint-Galloise a battu en deux manches la Française Gracheva jeudi. Elle affrontera Karolina Muchova au prochain tour.🕒 07:52 · 23 / 10 / 2025 | 📰 Source : partner-feeds.20min.ch


Le cycliste français emprisonné en Russie a été libéré
Accusé de «franchissement illégal de la frontière» russe, il avait été arrêté début septembre.🕒 07:52 · 23 / 10 / 2025 | 📰 Source : partner-feeds.20min.ch


Les États-Unis détruisent un bateau dans le Pacifique
Les États-Unis ont visé un bateau, tuant trois personnes dans le Pacifique, dans ce qu'ils présentent comme une frappe contre des narcotrafiquants, selon la Défense.🕒 07:41 · 23 / 10 / 2025 | 📰 Source : partner-feeds.20min.ch


Premières minutes en NBA pour Yanic Niederhäuser
Le Fribourgeois de 22 ans a inscrit quatre points pour ses débuts avec les Los Angeles Clippers mercredi.🕒 07:36 · 23 / 10 / 2025 | 📰 Source : partner-feeds.20min.ch


Meta supprime 600 emplois au sein de sa division IA
La décision de Meta vise à répondre à son «gonflement organisationnel», après une campagne de recrutement considérable.🕒 07:15 · 23 / 10 / 2025 | 📰 Source : partner-feeds.20min.ch


«Xi Jinping peut avoir une grande influence sur Poutine»
C'est ce qu'a déclaré Donald Trump aux journalistes, lors d’une rencontre avec le secrétaire général de l’OTAN, Mark Rutte, dans le Bureau ovale de la Maison-Blanche.🕒 07:06 · 23 / 10 / 2025 | 📰 Source : partner-feeds.20min.ch


Wemby sort le grand jeu pour son retour
Victor Wembanyama a inscrit 40 points avec les Spurs mercredi en NBA contre Dallas. Il n'avait plus joué de match officiel depuis huit mois.🕒 07:00 · 23 / 10 / 2025 | 📰 Source : partner-feeds.20min.ch


«Je ne sais pas quel est l’imbécile qui a lancé cette fake news»
Mercredi, l’influenceur Aqababe avait assuré sur ses réseaux sociaux que l’ancienne icône du cinéma français, âgée de 91 ans, était décédée.🕒 06:52 · 23 / 10 / 2025 | 📰 Source : partner-feeds.20min.ch


«Rentrez chez vous!»: des touristes attirent la colère des locaux
À Valence, une balade à vélo de touristes néerlandais a tourné court: le groupe s’est retrouvé au milieu d’une manifestation contre le tourisme de masse. Malgré les appels à mettre pied à terre, ils ont continué à rouler, jusqu’à ce que la situation dégénère.🕒 06:05 · 23 / 10 / 2025 | 📰 Source : partner-feeds.20min.ch


«Il y a beaucoup de surprises dans cet album»
Seraina Telli sort ce vendredi son nouvel album «Green». La chanteuse argovienne de 35 ans a accepté de nous faire son portrait à travers ses chansons.🕒 06:03 · 23 / 10 / 2025 | 📰 Source : partner-feeds.20min.ch


Une résidence envahie par les caddies empruntés à Coop
Dans un quartier argovien, les chariots débordent depuis que Coop, qui a reçu de nouveaux caddies, ne récupère plus les anciens que les clients ramenaient chez eux.🕒 06:01 · 23 / 10 / 2025 | 📰 Source : partner-feeds.20min.ch


Miser sur la soupe miso au petit-déjeuner
Le petit-déjeuner japonais gagne en popularité partout dans le monde et la soupe au miso est ainsi une bonne alternative aux menus traditionnels, pour plusieurs raisons.🕒 06:00 · 23 / 10 / 2025 | 📰 Source : partner-feeds.20min.ch


De plus en plus d'animaux abandonnés arrivent dans les refuges
La Protection suisse des animaux a révélé que 32'079 animaux ont été recueillis en 2024. Un chiffre qui a tendance à augmenter.🕒 22:35 · 22 / 10 / 2025 | 📰 Source : partner-feeds.20min.ch


Lola a dit: «Madame, s’il vous plaît, ne me faites pas de mal»
L'accusée a livré un témoignage peu en rapport avec les conclusions des médecins légistes. Son mobile n'apparaît guère plus clair.🕒 21:44 · 22 / 10 / 2025 | 📰 Source : partner-feeds.20min.ch


«C'est très dur et je m'en suis pris plein la tête»
Lola Dubini est revenue sur la grossophobie dont elle a été victime lors de la saison 11 de «Danse avec les stars». Elle déplore le manque de réaction de la chaîne.🕒 21:12 · 22 / 10 / 2025 | 📰 Source : partner-feeds.20min.ch


Crise entre assureurs et médecins: les patients en paient le prix
De nombreux assurés se voient refuser le remboursement de certains frais médicaux par leur complémentaire, car leur médecin n'a pas adhéré à un système tarifaire précis.🕒 20:42 · 22 / 10 / 2025 | 📰 Source : partner-feeds.20min.ch


Coq trop bruyant: la commune exige que la famille s'en débarrasse
Des habitants se sont plaints de nuisances causées par le coq d'un poulailler familial. Ses propriétaires ont été sommés de s'en séparer, mais ils refusent.🕒 20:39 · 22 / 10 / 2025 | 📰 Source : partner-feeds.20min.ch


Pendue il y a 70 ans, ses petits-enfants réclament sa grâce
Ses descendants sont persuadés que leur grand-mère aurait été jugée différemment si son procès avait eu lieu aujourd’hui, eu égard aux violences qu'elle aurait subies.🕒 20:35 · 22 / 10 / 2025 | 📰 Source : partner-feeds.20min.ch


Cette vidéo virale suscite de l'inquiétude et agace en Suisse
La vidéo de Magnus Midtbø escaladant seul le Cervin cartonne sur les réseaux. Les secouristes s’inquiètent des risques et des possibles imitations. (fch)🕒 20:34 · 22 / 10 / 2025 | 📰 Source : partner-feeds.20min.ch


Meurtre d'une ado: il la tue parce qu'elle voulait le plaquer
Âgé de 20 ans, le compagnon de la victime a été mis en examen pour homicide volontaire par conjoint et placé en détention provisoire.🕒 19:54 · 22 / 10 / 2025 | 📰 Source : partner-feeds.20min.ch


Un dérivé enrichi de la vitamine K pourrait inverser l'Alzheimer
Des chercheurs japonais ont créé un nouveau composé pour aider les cellules cérébrales immatures à se développer en neurones.🕒 19:28 · 22 / 10 / 2025 | 📰 Source : partner-feeds.20min.ch


Le boom des prothèses capillaires: «Ça a changé ma vie!»
De plus en plus d'hommes et de femmes ont recours aux prothèses capillaires, malgré un tabou tenace. La tendance se répand sur les réseaux comme une traînée de poudre.🕒 18:10 · 22 / 10 / 2025 | 📰 Source : partner-feeds.20min.ch


Disney a refusé un film centré sur Kylo Ren
Adam Driver a révélé que les studios Disney avaient rejeté une idée de script dédié à son personnage dans la saga «Star Wars».🕒 18:07 · 22 / 10 / 2025 | 📰 Source : partner-feeds.20min.ch


Éruptions cutanées à La Poste: colis chinois suspectés
Des employés du centre de colis à Frauenfeld ont signalé des problèmes de peau. La Suva n'a rien trouvé d'anormal mais deux élues insistent pour que l'on creuse.🕒 16:58 · 22 / 10 / 2025 | 📰 Source : partner-feeds.20min.ch


Ce pull vole la vedette au col roulé
Cet automne, fini le look col roulé! Le pull à col rond prend le relais. Voici quelques inspirations pour bien le porter dès les premières fraîcheurs de fin d'année.🕒 16:00 · 22 / 10 / 2025 | 📰 Source : partner-feeds.20min.ch


«Je suis restée deux jours dans un mutisme terrible»
Dans une story Instagram, Inès Vandamme a révélé qu'elle avait passé deux jours compliqués après une mauvaise nouvelle.🕒 15:53 · 22 / 10 / 2025 | 📰 Source : partner-feeds.20min.ch


Accusé d’avoir une Rolex, ce député de gauche dévoile la vérité
Louis Boyard, filmé en train d’enlever une prétendue montre de luxe avant de passer à la télé à l’Assemblée, a réagi dans une vidéo et dénonce une campagne de désinformation. (fch)🕒 15:34 · 22 / 10 / 2025 | 📰 Source : partner-feeds.20min.ch


Condamné pour viol, il faisait office de famille d'accueil
Deux hommes, ayant eu des démêlés avec la justice il y a plusieurs décennies, étaient inscrits dans le dispositif de familles d'accueil.🕒 15:30 · 22 / 10 / 2025 | 📰 Source : partner-feeds.20min.ch


Les requérants d'asile ne pourront plus voyager à l'étranger
Désormais, les personnes relevant de l’asile ne pourront plus voyager à l’étranger, sauf exception. Les Ukrainiens sous statut S ne sont pas concernés par cette mesure.🕒 14:54 · 22 / 10 / 2025 | 📰 Source : partner-feeds.20min.ch


Collision mortelle entre une voiture et un camion à Muttenz
Une conductrice de 76 ans a perdu la vie mardi après-midi dans le canton de Bâle-Campagne. Elle a dévié de sa trajectoire et percuté un camion de plein fouet.🕒 14:16 · 22 / 10 / 2025 | 📰 Source : partner-feeds.20min.ch


Un couple se fait voler ses plaques de voiture en Espagne
En vacances à Valence, ces Suisses ont eu la mauvaise surprise de découvrir leur véhicule sans plaques d'immatriculation. Le cas n'est pas rare, selon un assureur.🕒 13:40 · 22 / 10 / 2025 | 📰 Source : partner-feeds.20min.ch


Les robotaxis de Baidu débarquent en Suisse en décembre
Le géant chinois commencera les essais de ses taxis autonomes dans trois cantons, en partenariat avec CarPostal, à la fin de l'année.🕒 13:39 · 22 / 10 / 2025 | 📰 Source : partner-feeds.20min.ch


Pour vous informer, préférez les médias traditionnels à ChatGPT
Pour s'informer, les IA comme ChatGPT ne sont pas dignes de confiance, selon une étude réalisée par vingt-deux médias publics de dix-huit pays européens.🕒 12:17 · 22 / 10 / 2025 | 📰 Source : partner-feeds.20min.ch


Attention aux antidépresseurs, chacun (ré)agit différemment
Une étude publiée dans «The Lancet» met en garde contre les effets secondaires de ces médicaments, qui peuvent fortement varier d'un patient et d'un produit à l'autre.🕒 12:09 · 22 / 10 / 2025 | 📰 Source : partner-feeds.20min.ch


Une musicienne retrouve l’usage de ses doigts en pleine chirurgie
Le 21 octobre 2025, l’hôpital King’s College de Londres a révélé qu’une patiente atteinte de Parkinson avait joué de la clarinette pendant une opération du cerveau. L’intervention, menée en juillet, a permis à Denise Bacon, 65 ans, de retrouver la mobilité de ses doigts grâce à la stimulation cérébrale profonde. (chs)🕒 11:48 · 22 / 10 / 2025 | 📰 Source : partner-feeds.20min.ch


Cette faute énorme lui vaut un carton rouge historique
Trois minutes de jeu et déjà dehors: João Correia, attaquant de Paphos (Chypre), a été expulsé pour un geste dangereux au visage d’un joueur du Kairat Almaty (Kazakhstan). C’est la deuxième exclusion la plus rapide de l’histoire de la C1. (fch)🕒 11:47 · 22 / 10 / 2025 | 📰 Source : partner-feeds.20min.ch


Une Suissesse de 17 ans a brillé à la Fashion Week de New York
À 16 ans, Mary a remporté un concours de mannequinat à Zurich. Peu de temps après, elle défilait déjà à New York pour deux créateurs. Son parcours parle de lui-même.🕒 11:45 · 22 / 10 / 2025 | 📰 Source : partner-feeds.20min.ch


OpenAI défie Google Chrome avec son propre navigateur dopé à l’IA
L'entreprise de Sam Altman a dévoilé son navigateur ChatGPT Atlas, intégrant l'IA pour transformer l'expérience de navigation.🕒 10:48 · 22 / 10 / 2025 | 📰 Source : partner-feeds.20min.ch


Des millions de lampes illuminent la ville indienne d’Ayodhya
La ville indienne d’Ayodhya a brillé de mille feux à la veille de Diwali, en allumant plus de 2,6 millions de lampes à huile, un record. (atk)🕒 10:03 · 22 / 10 / 2025 | 📰 Source : partner-feeds.20min.ch


Les agriculteurs ne savent plus quoi faire de leurs patates
Des pommes de terre de qualité supérieure sont produites en abondance, mais le manque d'acheteurs se fait sentir.🕒 10:02 · 22 / 10 / 2025 | 📰 Source : partner-feeds.20min.ch


L’Allemagne va payer les employés de l’armée américaine
La paralysie budgétaire aux États-Unis menace les employés en Allemagne des bases américaines.🕒 09:43 · 22 / 10 / 2025 | 📰 Source : partner-feeds.20min.ch


Arrêter de fumer, même tard, réduit les risques de démence
Selon une étude publiée dans «The Lancet», le déclin de la mémoire est ralenti chez les ex-fumeurs, comparé à ceux qui ne renoncent pas au tabagisme.🕒 08:09 · 22 / 10 / 2025 | 📰 Source : partner-feeds.20min.ch


La cryptomonnaie de Melania Trump était-elle une arnaque?
Les architectes de la cryptomonnaie de la première dame des États-Unis sont soupçonnés d'avoir mis sur pied une escroquerie de grande ampleur pour empocher des bénéfices.🕒 07:47 · 22 / 10 / 2025 | 📰 Source : partner-feeds.20min.ch


Pollution, stress, apnée: ces risques négligés qui mènent à l'AVC
Toutes les 30 minutes, une personne fait un AVC en Suisse. Les facteurs de risque sont connus: hypertension, diabète, cholestérol, tabac. Mais ce ne sont pas les seuls.🕒 06:11 · 22 / 10 / 2025 | 📰 Source : partner-feeds.20min.ch


«Je peux gentiment montrer ma vraie facette»
Avec son nouvel EP «Patti Person», la chanteuse Silance casse son image et prend un nouveau départ.🕒 06:09 · 22 / 10 / 2025 | 📰 Source : partner-feeds.20min.ch


L'utilité de prendre un «jour invisible»
Vous vous sentez stressé et submergé par la vie, le travail et les réseaux sociaux? Il est peut-être temps de vous rendre invisible durant une journée.🕒 06:00 · 22 / 10 / 2025 | 📰 Source : partner-feeds.20min.ch


Qui va s'adjuger la guitare mythique de la séparation d'Oasis?
La Gibson rouge sang ne passera pas inaperçue, lors de cette vente organisée à Londres. Elle côtoiera sans complexe les lunettes de Lennon ou celles du King.🕒 20:12 · 21 / 10 / 2025 | 📰 Source : partner-feeds.20min.ch


Des moustiques arrivent pour la première fois en Islande
L'île nordique était l'un des rares territoires habités exempts de ce genre d'insectes, mais ces derniers auraient profité de navires commerciaux pour débarquer.🕒 19:32 · 21 / 10 / 2025 | 📰 Source : partner-feeds.20min.ch


L'algorithme de TikTok pousse-t-il nos ados au suicide?
Amnesty International s'est mis dans la peau d'adolescents de 13 ans et tire la sonnette d'alarme.🕒 16:40 · 21 / 10 / 2025 | 📰 Source : partner-feeds.20min.ch


Liquide vaisselle: à proscrire dans une cafetière italienne
Nettoyer cet appareil avec du liquide vaisselle est vu comme un sacrilège par les amateurs de café. Selon eux, elle ne doit être rincée qu'à l'eau.🕒 16:00 · 21 / 10 / 2025 | 📰 Source : partner-feeds.20min.ch


Pavel Durov prêt à racheter le butin pour le Louvre… d’Abu Dhabi
Le fondateur de la messagerie Telegram a commenté le casse spectaculaire au musée parisien en le présentant comme un symbole du déclin de la France.🕒 15:42 · 21 / 10 / 2025 | 📰 Source : partner-feeds.20min.ch


Comment les agriculteurs peuvent se passer de pesticides
Produire suffisamment de denrées alimentaires sans polluer? En Suisse, le projet HofLabor prouve qu’une agriculture sans pesticides ni engrais chimiques est possible.🕒 11:00 · 21 / 10 / 2025 | 📰 Source : partner-feeds.20min.ch


«Les responsabilités peuvent aller avec les rêves»
Suzane est de retour avec un troisième album. «Millénium» se veut son œuvre la plus intime et la plus engagée à ce jour.🕒 06:16 · 21 / 10 / 2025 | 📰 Source : partner-feeds.20min.ch


Taylor Swift propulse Portofino: hausse de 1329% des recherches
Dans son nouvel album, la chanteuse américaine mentionne la station balnéaire italienne. Depuis, les recherches la concernant ont augmenté de 1329%.🕒 06:00 · 21 / 10 / 2025 | 📰 Source : partner-feeds.20min.ch


«Je ne promets pas de faire rire, je ne sais pas le faire»
Quatre ans après «Kaamelott: premier volet», les hilarantes aventures du roi Arthur reviennent en salle. Le créateur de la saga culte, Alexandre Astier, raconte.🕒 21:32 · 20 / 10 / 2025 | 📰 Source : partner-feeds.20min.ch


WhatsApp serre la vis en limitant les messages aux inconnus
Le service de messagerie tente de résoudre son problème de messages non sollicités en bloquant le nombre d'envois que les utilisateurs ou entreprises peuvent effectuer.🕒 19:21 · 20 / 10 / 2025 | 📰 Source : partner-feeds.20min.ch


Un «Scream Club» permet d’évacuer son stress en hurlant
Le calme habituel qui règne sur la colline d’Hampstead Heath a été troublé par une bande de jeunes décidés à se débarrasser sur place de leur surplus de stress.🕒 16:34 · 20 / 10 / 2025 | 📰 Source : partner-feeds.20min.ch


Voici la bière la plus petite du monde!
Le brasseur danois Carlsberg a créé la plus petite bière du monde pour sensibiliser à la consommation responsable, a-t-il annoncé lundi.🕒 16:11 · 20 / 10 / 2025 | 📰 Source : partner-feeds.20min.ch


Sacs à main de créateurs: un placement inestimable
Ces accessoires de luxe griffés sont des investissements convoités par un nombre croissant de jeunes femmes. Une experte, employée par Sotheby's, nous explique la raison.🕒 16:00 · 20 / 10 / 2025 | 📰 Source : partner-feeds.20min.ch


Meta enterre l'app Messenger sur Mac et Windows
Les utilisateurs du service de messagerie sur ordinateur seront bientôt obligés de migrer vers sa version web.🕒 11:13 · 20 / 10 / 2025 | 📰 Source : partner-feeds.20min.ch


Retour progressif à la normale après une panne mondiale
Une partie d'Internet et des applications au cœur du quotidien de millions de personnes se sont grippés lundi.🕒 10:27 · 20 / 10 / 2025 | 📰 Source : partner-feeds.20min.ch


Ils se tirent les oreilles pour lutter contre le stress
Se pincer le lobe de l'oreille ferait baisser le stress, selon certains thérapeutes. Cette technique de relaxation rapide a en tout cas du succès sur TikTok.🕒 06:00 · 20 / 10 / 2025 | 📰 Source : partner-feeds.20min.ch


Qui est Léa? La candidate suisse qui est entrée au château
Venue de Suisse, Léa fait partie des nouveaux élèves qui ont franchi, samedi soir, les portes du château de Dammarie-lès-Lys.🕒 13:50 · 19 / 10 / 2025 | 📰 Source : partner-feeds.20min.ch


Pour un pain plus sain, congelez-le avant de le griller
Grâce à un processus chimique, le pain congelé puis réchauffé est plus sain et permet d'éviter les pics de glycémie.🕒 08:00 · 19 / 10 / 2025 | 📰 Source : partner-feeds.20min.ch


À quoi sert le petit trou sur la poignée d'un aspirateur?
Vous avez peut-être déjà remarqué l'ouverture située sur la poignée de votre aspirateur. Elle a une fonction bien précise et très utile.🕒 08:00 · 18 / 10 / 2025 | 📰 Source : partner-feeds.20min.ch


Il faudra peut-être bientôt payer pour visiter la Thaïlande
L'instauration d'une taxe touristique suscite le débat depuis des années en Thaïlande. Un nouveau ministre entend désormais la faire appliquer.🕒 16:00 · 17 / 10 / 2025 | 📰 Source : partner-feeds.20min.ch


Le captage du carbone est sous pression
Climeworks, pionnière du captage du CO₂ dans l’air, a subi une série de revers en 2025. Sa technologie incarne-t-elle l’avenir ou s'agit-il d'un simple effet de mode?🕒 11:00 · 17 / 10 / 2025 | 📰 Source : partner-feeds.20min.ch


Le pantalon en daim fait son grand retour
Le pantalon en daim était déjà porté par les icônes de la mode des années 1960. Cette saison, il s'impose comme un incontournable chez les fashionistas.🕒 06:00 · 17 / 10 / 2025 | 📰 Source : partner-feeds.20min.ch


Et si vous débarrassiez de votre peur de déranger?
Il arrive qu'on n'ose pas contacter ses proches par peur de paraître envahissant. Pourtant, une étude démontre que la démarche est plus appréciée qu'on ne le pense.🕒 16:00 · 16 / 10 / 2025 | 📰 Source : partner-feeds.20min.ch


Escapade gourmande en Géorgie durant les vendanges
Ce pays, berceau de la viticulture il y a 8000 ans, se distingue par une cuisine singulière, située au carrefour des influences européenne, turque et iranienne.🕒 06:00 · 16 / 10 / 2025 | 📰 Source : partner-feeds.20min.ch


Trottinette et alcool = retrait de permis?
Conduire une trottinette électrique en état d'ébriété peut coûter plus qu'une amende. À partir d'une certaine d'alcoolémie, on risque un retrait du permis de conduire.🕒 16:00 · 15 / 10 / 2025 | 📰 Source : partner-feeds.20min.ch


Le créateur d'affiches mythiques du cinéma est décédé
Drew Struzan, l’artiste américain derrière les affiches emblématiques de «Star Wars», «Indiana Jones» ou «Retour vers le futur», est mort à l’âge de 78 ans.🕒 11:51 · 15 / 10 / 2025 | 📰 Source : partner-feeds.20min.ch


«Quand j'arrive sur un plateau, je me sens à ma place»
À l'affiche du film «Chien 51», Adèle Exarchopoulos incarne une policière d'élite dans un futur proche et inquiétant. Jouer la comédie la passionne toujours autant.🕒 07:07 · 15 / 10 / 2025 | 📰 Source : partner-feeds.20min.ch


Combien de temps un chien peut-il rester seul?
Les chiens sont des animaux de meute à qui la solitude pèse. Selon une experte canine, ils peuvent rester seuls trois ou quatre heures par jour.🕒 06:00 · 15 / 10 / 2025 | 📰 Source : partner-feeds.20min.ch


Que faire des plantes sur le balcon en octobre?
Il commence à faire froid. Le moment est venu de faire les dernières récoltes et de rentrer certaines plantes.🕒 16:00 · 14 / 10 / 2025 | 📰 Source : partner-feeds.20min.ch


Cette ville britannique méconnue serait la plus belle du monde
Une étude s'est penchée sur le nombre de bâtiments d'une ville pour lesquels le nombre d'or s'applique. L'objectif était de déterminer la plus belle ville du monde.🕒 06:00 · 14 / 10 / 2025 | 📰 Source : partner-feeds.20min.ch


La douche express est-elle vraiment suffisante?
Plusieurs célébrités misent sur des douches de courte durée pour le bien de leur peau et de l'environnement. Bonne ou mauvaise idée? Une dermatologue fait le point.🕒 16:00 · 13 / 10 / 2025 | 📰 Source : partner-feeds.20min.ch


Reconnaissez-vous l’acteur derrière le tueur Ed Gein sur Netflix?
Ce visage de Ed Gein dans Monster vous semble familier ? C’est normal. Sous les traits du célèbre tueur se trouve Charlie Hunnam, l’acteur anglais de 45 ans qu’on a déjà vu dans plusieurs rôles marquants.🕒 13:25 · 13 / 10 / 2025 | 📰 Source : partner-feeds.20min.ch


Comment paraître instantanément plus sympathique
Il existe des astuces pour gagner en popularité auprès de ses collègues. Cela va du choix du siège en salle de réunion à la façon de conclure une conversation.🕒 06:00 · 13 / 10 / 2025 | 📰 Source : partner-feeds.20min.ch


Gagne tes places pour LHC–HC Davos et rencontre un joueur !
Tente de remporter tes billets et un Meet & Greet à la fin du match entre le Lausanne HC et le HC Davos qui aura lieu le 29 octobre à la Vaudoise aréna.🕒 00:01 · 13 / 10 / 2025 | 📰 Source : partner-feeds.20min.ch


De la bonne bagarre comme on l’aime tant
Dans un monde ravagé par la tyrannie et la magie déchue,«Absolum» mêle baston classique en 2D et roguelite, offrant des combats nerveux.🕒 19:52 · 12 / 10 / 2025 | 📰 Source : partner-feeds.20min.ch


Trente ans après, les jeux de combat loin du K.-O.
L’Evo France, plus grand tournoi européen de jeux de baston, a rassemblé des milliers de fans à Nice, confirmant la vitalité d’une scène née dans les salles d’arcade.🕒 17:30 · 12 / 10 / 2025 | 📰 Source : partner-feeds.20min.ch


Test de dépistage positif à cause d'un bagel au pavot?
Si manger un petit pain au pavot n'a pas de quoi inquiéter, il est néanmoins préférable de s'en abstenir avant un test de dépistage.🕒 08:00 · 12 / 10 / 2025 | 📰 Source : partner-feeds.20min.ch


Cette coiffure agit comme une opération de chirurgie esthétique
Le «bleph bun» a le même effet qu'une blépharoplastie. Il ne faut toutefois pas en abuser, au risque de provoquer une chute des cheveux.🕒 08:00 · 11 / 10 / 2025 | 📰 Source : partner-feeds.20min.ch


Prix, autonomie, puissance: la première Ferrari électrique arrive
Alors que le modèle définitif sera présenté début 2026, la marque au cheval cabré a donné des détails sur L’Elettrica, sa première voiture électrique.🕒 11:03 · 09 / 10 / 2025 | 📰 Source : partner-feeds.20min.ch


«Unyielder», des combats de boss de fous furieux
Ce titre indépendant propose une succession de combats de boss intenses et spectaculaires, portés par un gameplay nerveux et une direction artistique exemplaire.🕒 06:13 · 09 / 10 / 2025 | 📰 Source : partner-feeds.20min.ch


Pourquoi l'emplacement de la trappe à carburant varie-t-il?
En fonction des marques et des modèles, la trappe à carburant se trouve tantôt à gauche, tantôt à droite, voire à l'avant. Pourquoi?🕒 06:00 · 09 / 10 / 2025 | 📰 Source : partner-feeds.20min.ch


À partir de quelle température faut-il allumer le chauffage?
Il ne faut pas attendre d'avoir froid pour allumer le chauffage, mais le mettre en route dès que le mercure baisse afin d'éviter les dégâts dus au gel et les moisissures.🕒 16:00 · 07 / 10 / 2025 | 📰 Source : partner-feeds.20min.ch


Record historique à plus de 125'000 dollars pour le bitcoin
Le bitcoin a franchi un nouveau sommet dimanche matin pour atteindre 125'245,57 dollars, un record pour la première cryptomonnaie mondiale.🕒 08:08 · 05 / 10 / 2025 | 📰 Source : partner-feeds.20min.ch


Sur le bitume, Sonic n’a rien à envier à Mario
Grâce à ses portails dimensionnels et ses 39 circuits, «Sonic Racing: CrossWorlds» ose rivaliser avec «Mario Kart».🕒 07:19 · 03 / 10 / 2025 | 📰 Source : partner-feeds.20min.ch


Du trading à la sauce e-sport en Corée du Sud
Un événement inédit, mariant le monde de la finance et des cryptomonnaies à celui des compétitions de jeux vidéo, a fait sensation sur les réseaux sociaux.🕒 18:34 · 30 / 09 / 2025 | 📰 Source : partner-feeds.20min.ch


A-t-on le droit d'accélérer quand une voiture essaie de dépasser?
Si un véhicule veut vous doubler, vous devez lui fournir de l'espace pour lui permettre de vous dépasser et de se rabattre. Vous ne devez jamais accélérer.🕒 16:00 · 25 / 09 / 2025 | 📰 Source : partner-feeds.20min.ch


Chirurgie esthétique: les cinq opérations les plus risquées
La liposuccion, la rhinoplastie, le body contouring, le Brazilian butt lift et la blépharoplastie sont des interventions particulièrement délicates.🕒 06:00 · 12 / 09 / 2025 | 📰 Source : partner-feeds.20min.ch


Le calvaire d'un jeune Vaudois torturé pendant quatre jours
On en sait plus sur le jeune homme séquestré du 28 au 31 août, avant d’être libéré dans un raid de l’unité d’élite de la gendarmerie près de la gare de Valence (F).🕒 22:00 · 05 / 09 / 2025 | 📰 Source : partner-feeds.20min.ch


Tatouage ou grain de beauté?
La dernière tendance en date en matière de tatouages consiste à réaliser des motifs si discrets qu'ils sont à peine visibles à l'œil nu.🕒 06:00 · 03 / 09 / 2025 | 📰 Source : partner-feeds.20min.ch


Résultats et classements des championnats européens
Retrouvez les résultats de chaque journée et les classements des plus grands championnats européens de football.🕒 15:47 · 14 / 02 / 2025 | 📰 Source : partner-feeds.20min.ch


Le système du commerce mondial «risque de dérailler», dit l’ONU
Suivez l'actualité économique en Suisse et dans le monde.🕒 11:21 · 16 / 01 / 2024 | 📰 Source : partner-feeds.20min.ch


«Israël ne doit pas recourir à la famine comme méthode de guerre»
Israël et le Hamas sont parvenus à un accord sur un cessez-le-feu, une étape majeure visant à mettre fin à deux ans de guerre destructrice à Gaza.🕒 10:46 · 16 / 01 / 2024 | 📰 Source : partner-feeds.20min.ch


Zelensky salue les sanctions américaines contre Moscou
Suivez l'actualité du conflit et les tensions entre Moscou et l'Occident depuis le début de la guerre en février 2022.🕒 11:23 · 21 / 01 / 2022 | 📰 Source : partner-feeds.20min.ch


La nouvelle vie mouvementée du suspect de l'affaire Maddie
Libéré en septembre, l'Allemand Christian Brückner vit désormais dans la rue, dans le nord de l'Allemagne.🕒 11:19 · 23 / 10 / 2025 | 📰 Source : partner-feeds.20min.ch


Mis en examen à 13 ans après le viol filmé d’un garçon de 9 ans
Un adolescent a été mis en examen après avoir filmé un viol sur un enfant de 9 ans par un autre petit garçon.🕒 11:09 · 23 / 10 / 2025 | 📰 Source : partner-feeds.20min.ch


Une vidéo d’un influenceur gravissant seul le Cervin fait le buzz
Skip Pannatier, guide de montagne à Zermatt, nous fait part de son inquiétude de voir une vidéo de l’ascension du Cervin entrainer des comportements dangereux.🕒 11:00 · 23 / 10 / 2025 | 📰 Source : partner-feeds.20min.ch


Nouvelles règles dans le cadre du transfert de Moutier
Deux nouveaux accords liés au transfert de Moutier ont été signés par les cantons de Berne et du Jura. Le premier, sur la police, entre en vigueur le 15 novembre.🕒 10:32 · 23 / 10 / 2025 | 📰 Source : partner-feeds.20min.ch


Les premières images de la tempête Benjamin
La première tempête automnale de l’année frappe la Suisse avec des vents violents. Une pointe à 131 km/h a été mesurée aux Diablerets. (chs)🕒 10:13 · 23 / 10 / 2025 | 📰 Source : partner-feeds.20min.ch


Revue et Cirque de Noël se disputent la Plaine de Plainpalais
Le spectacle satirique devrait s’installer sur l’espace à partir de 2026. Mais le Cirque a saisi la justice.🕒 10:13 · 23 / 10 / 2025 | 📰 Source : partner-feeds.20min.ch


Poursuivie pour plagiat dans un titre mentionnant Sydney Sweeney
La chanteuse Lizzo est poursuivie devant un tribunal californien pour plagiat. Les faits concernent un extrait d'un titre non publié.🕒 10:11 · 23 / 10 / 2025 | 📰 Source : partner-feeds.20min.ch


Trump manque-t-il vraiment de «courage et d'intégrité»?
Les propos attribués au président du comité Nobel affirmant que «courage et intégrité» manquaient à Donald Trump sont faux. Ils ont été déformés. (fch)🕒 10:01 · 23 / 10 / 2025 | 📰 Source : partner-feeds.20min.ch


«Il était en train de coucher avec ma mère»
En Pennsylvanie, un homme de 55 ans aurait été abattu par le fils de sa nouvelle compagne, furieux de les avoir surpris en plein acte sexuel.🕒 10:00 · 23 / 10 / 2025 | 📰 Source : partner-feeds.20min.ch


Décos de Noël éteintes pendant la nuit: la polémique enfle
Le canton du Valais souhaite lutter contre la pollution lumineuse publique et privée entre minuit et 6h du matin. À peine envisagé, le projet fait déjà des remous.🕒 10:00 · 23 / 10 / 2025 | 📰 Source : partner-feeds.20min.ch


La police de l’immigration de Trump dépense sans compter
Alors que d’autres agences gouvernementales fonctionnent au ralenti en raison de la fermeture partielle de l’administration, l’ICE est largement épargnée.🕒 09:16 · 23 / 10 / 2025 | 📰 Source : partner-feeds.20min.ch


En soins intensifs après des injections illégales de Botox
Des cas graves de botulisme ont été signalés en France après des injections illégales de toxine botulinique, par des personnes «non habilitées».🕒 08:53 · 23 / 10 / 2025 | 📰 Source : partner-feeds.20min.ch


Comment Stan Wawrinka lutte contre le trac en vieillissant
À 40 ans, le Vaudois est souvent très nerveux avant un match. Et cela ne s'arrange pas sous les yeux de ses fans aux Swiss Indoors de Bâle.🕒 08:18 · 23 / 10 / 2025 | 📰 Source : partner-feeds.20min.ch


Les soins capillaires lissants, passeport pour le cancer?
Certains de ces produits contiennent un composé chimique qui fait exploser le risque de cancer du pancréas ou de la thyroïde, alerte une étude américaine.🕒 08:17 · 23 / 10 / 2025 | 📰 Source : partner-feeds.20min.ch


Ligne haute tension au sol, chutes d'arbres: il y a des dégâts
La première tempête automnale frappe la Suisse avec des vents violents. Une pointe à 131 km/h a été mesurée aux Diablerets.🕒 08:15 · 23 / 10 / 2025 | 📰 Source : partner-feeds.20min.ch


Adel des 2be3: «On était trois amis avant d'être un boys band»
La série «Culte–2Be3» sort le 24 octobre sur Prime Video. Membre du trio, Adel Kachermi, qui travaille à Genève dans la conciergerie de luxe, revient sur cette aventure.🕒 08:11 · 23 / 10 / 2025 | 📰 Source : partner-feeds.20min.ch


Il tente tout pour déduire des barres protéinées de ses impôts
Un Bernois qui se rend au travail à vélo s'est battu, en vain, pour pouvoir soustraire de sa déclaration d'impôts près de 3400 fr. de frais liés à son mode de transport.🕒 08:10 · 23 / 10 / 2025 | 📰 Source : partner-feeds.20min.ch


Belinda Bencic en quarts à Tokyo
La Saint-Galloise a battu en deux manches la Française Gracheva jeudi. Elle affrontera Karolina Muchova au prochain tour.🕒 07:52 · 23 / 10 / 2025 | 📰 Source : partner-feeds.20min.ch


Le cycliste français emprisonné en Russie a été libéré
Accusé de «franchissement illégal de la frontière» russe, il avait été arrêté début septembre.🕒 07:52 · 23 / 10 / 2025 | 📰 Source : partner-feeds.20min.ch


Les États-Unis détruisent un bateau dans le Pacifique
Les États-Unis ont visé un bateau, tuant trois personnes dans le Pacifique, dans ce qu'ils présentent comme une frappe contre des narcotrafiquants, selon la Défense.🕒 07:41 · 23 / 10 / 2025 | 📰 Source : partner-feeds.20min.ch


Premières minutes en NBA pour Yanic Niederhäuser
Le Fribourgeois de 22 ans a inscrit quatre points pour ses débuts avec les Los Angeles Clippers mercredi.🕒 07:36 · 23 / 10 / 2025 | 📰 Source : partner-feeds.20min.ch


Meta supprime 600 emplois au sein de sa division IA
La décision de Meta vise à répondre à son «gonflement organisationnel», après une campagne de recrutement considérable.🕒 07:15 · 23 / 10 / 2025 | 📰 Source : partner-feeds.20min.ch


«Xi Jinping peut avoir une grande influence sur Poutine»
C'est ce qu'a déclaré Donald Trump aux journalistes, lors d’une rencontre avec le secrétaire général de l’OTAN, Mark Rutte, dans le Bureau ovale de la Maison-Blanche.🕒 07:06 · 23 / 10 / 2025 | 📰 Source : partner-feeds.20min.ch


Wemby sort le grand jeu pour son retour
Victor Wembanyama a inscrit 40 points avec les Spurs mercredi en NBA contre Dallas. Il n'avait plus joué de match officiel depuis huit mois.🕒 07:00 · 23 / 10 / 2025 | 📰 Source : partner-feeds.20min.ch


«Je ne sais pas quel est l’imbécile qui a lancé cette fake news»
Mercredi, l’influenceur Aqababe avait assuré sur ses réseaux sociaux que l’ancienne icône du cinéma français, âgée de 91 ans, était décédée.🕒 06:52 · 23 / 10 / 2025 | 📰 Source : partner-feeds.20min.ch


«Rentrez chez vous!»: des touristes attirent la colère des locaux
À Valence, une balade à vélo de touristes néerlandais a tourné court: le groupe s’est retrouvé au milieu d’une manifestation contre le tourisme de masse. Malgré les appels à mettre pied à terre, ils ont continué à rouler, jusqu’à ce que la situation dégénère.🕒 06:05 · 23 / 10 / 2025 | 📰 Source : partner-feeds.20min.ch


«Il y a beaucoup de surprises dans cet album»
Seraina Telli sort ce vendredi son nouvel album «Green». La chanteuse argovienne de 35 ans a accepté de nous faire son portrait à travers ses chansons.🕒 06:03 · 23 / 10 / 2025 | 📰 Source : partner-feeds.20min.ch


Une résidence envahie par les caddies empruntés à Coop
Dans un quartier argovien, les chariots débordent depuis que Coop, qui a reçu de nouveaux caddies, ne récupère plus les anciens que les clients ramenaient chez eux.🕒 06:01 · 23 / 10 / 2025 | 📰 Source : partner-feeds.20min.ch


Miser sur la soupe miso au petit-déjeuner
Le petit-déjeuner japonais gagne en popularité partout dans le monde et la soupe au miso est ainsi une bonne alternative aux menus traditionnels, pour plusieurs raisons.🕒 06:00 · 23 / 10 / 2025 | 📰 Source : partner-feeds.20min.ch


De plus en plus d'animaux abandonnés arrivent dans les refuges
La Protection suisse des animaux a révélé que 32'079 animaux ont été recueillis en 2024. Un chiffre qui a tendance à augmenter.🕒 22:35 · 22 / 10 / 2025 | 📰 Source : partner-feeds.20min.ch


Lola a dit: «Madame, s’il vous plaît, ne me faites pas de mal»
L'accusée a livré un témoignage peu en rapport avec les conclusions des médecins légistes. Son mobile n'apparaît guère plus clair.🕒 21:44 · 22 / 10 / 2025 | 📰 Source : partner-feeds.20min.ch


«C'est très dur et je m'en suis pris plein la tête»
Lola Dubini est revenue sur la grossophobie dont elle a été victime lors de la saison 11 de «Danse avec les stars». Elle déplore le manque de réaction de la chaîne.🕒 21:12 · 22 / 10 / 2025 | 📰 Source : partner-feeds.20min.ch


Crise entre assureurs et médecins: les patients en paient le prix
De nombreux assurés se voient refuser le remboursement de certains frais médicaux par leur complémentaire, car leur médecin n'a pas adhéré à un système tarifaire précis.🕒 20:42 · 22 / 10 / 2025 | 📰 Source : partner-feeds.20min.ch


Coq trop bruyant: la commune exige que la famille s'en débarrasse
Des habitants se sont plaints de nuisances causées par le coq d'un poulailler familial. Ses propriétaires ont été sommés de s'en séparer, mais ils refusent.🕒 20:39 · 22 / 10 / 2025 | 📰 Source : partner-feeds.20min.ch


Pendue il y a 70 ans, ses petits-enfants réclament sa grâce
Ses descendants sont persuadés que leur grand-mère aurait été jugée différemment si son procès avait eu lieu aujourd’hui, eu égard aux violences qu'elle aurait subies.🕒 20:35 · 22 / 10 / 2025 | 📰 Source : partner-feeds.20min.ch


Cette vidéo virale suscite de l'inquiétude et agace en Suisse
La vidéo de Magnus Midtbø escaladant seul le Cervin cartonne sur les réseaux. Les secouristes s’inquiètent des risques et des possibles imitations. (fch)🕒 20:34 · 22 / 10 / 2025 | 📰 Source : partner-feeds.20min.ch


Meurtre d'une ado: il la tue parce qu'elle voulait le plaquer
Âgé de 20 ans, le compagnon de la victime a été mis en examen pour homicide volontaire par conjoint et placé en détention provisoire.🕒 19:54 · 22 / 10 / 2025 | 📰 Source : partner-feeds.20min.ch


Un dérivé enrichi de la vitamine K pourrait inverser l'Alzheimer
Des chercheurs japonais ont créé un nouveau composé pour aider les cellules cérébrales immatures à se développer en neurones.🕒 19:28 · 22 / 10 / 2025 | 📰 Source : partner-feeds.20min.ch


Le boom des prothèses capillaires: «Ça a changé ma vie!»
De plus en plus d'hommes et de femmes ont recours aux prothèses capillaires, malgré un tabou tenace. La tendance se répand sur les réseaux comme une traînée de poudre.🕒 18:10 · 22 / 10 / 2025 | 📰 Source : partner-feeds.20min.ch


Disney a refusé un film centré sur Kylo Ren
Adam Driver a révélé que les studios Disney avaient rejeté une idée de script dédié à son personnage dans la saga «Star Wars».🕒 18:07 · 22 / 10 / 2025 | 📰 Source : partner-feeds.20min.ch


Éruptions cutanées à La Poste: colis chinois suspectés
Des employés du centre de colis à Frauenfeld ont signalé des problèmes de peau. La Suva n'a rien trouvé d'anormal mais deux élues insistent pour que l'on creuse.🕒 16:58 · 22 / 10 / 2025 | 📰 Source : partner-feeds.20min.ch


Ce pull vole la vedette au col roulé
Cet automne, fini le look col roulé! Le pull à col rond prend le relais. Voici quelques inspirations pour bien le porter dès les premières fraîcheurs de fin d'année.🕒 16:00 · 22 / 10 / 2025 | 📰 Source : partner-feeds.20min.ch


«Je suis restée deux jours dans un mutisme terrible»
Dans une story Instagram, Inès Vandamme a révélé qu'elle avait passé deux jours compliqués après une mauvaise nouvelle.🕒 15:53 · 22 / 10 / 2025 | 📰 Source : partner-feeds.20min.ch


Accusé d’avoir une Rolex, ce député de gauche dévoile la vérité
Louis Boyard, filmé en train d’enlever une prétendue montre de luxe avant de passer à la télé à l’Assemblée, a réagi dans une vidéo et dénonce une campagne de désinformation. (fch)🕒 15:34 · 22 / 10 / 2025 | 📰 Source : partner-feeds.20min.ch


Condamné pour viol, il faisait office de famille d'accueil
Deux hommes, ayant eu des démêlés avec la justice il y a plusieurs décennies, étaient inscrits dans le dispositif de familles d'accueil.🕒 15:30 · 22 / 10 / 2025 | 📰 Source : partner-feeds.20min.ch


Les requérants d'asile ne pourront plus voyager à l'étranger
Désormais, les personnes relevant de l’asile ne pourront plus voyager à l’étranger, sauf exception. Les Ukrainiens sous statut S ne sont pas concernés par cette mesure.🕒 14:54 · 22 / 10 / 2025 | 📰 Source : partner-feeds.20min.ch


Collision mortelle entre une voiture et un camion à Muttenz
Une conductrice de 76 ans a perdu la vie mardi après-midi dans le canton de Bâle-Campagne. Elle a dévié de sa trajectoire et percuté un camion de plein fouet.🕒 14:16 · 22 / 10 / 2025 | 📰 Source : partner-feeds.20min.ch


Un couple se fait voler ses plaques de voiture en Espagne
En vacances à Valence, ces Suisses ont eu la mauvaise surprise de découvrir leur véhicule sans plaques d'immatriculation. Le cas n'est pas rare, selon un assureur.🕒 13:40 · 22 / 10 / 2025 | 📰 Source : partner-feeds.20min.ch


Les robotaxis de Baidu débarquent en Suisse en décembre
Le géant chinois commencera les essais de ses taxis autonomes dans trois cantons, en partenariat avec CarPostal, à la fin de l'année.🕒 13:39 · 22 / 10 / 2025 | 📰 Source : partner-feeds.20min.ch


Pour vous informer, préférez les médias traditionnels à ChatGPT
Pour s'informer, les IA comme ChatGPT ne sont pas dignes de confiance, selon une étude réalisée par vingt-deux médias publics de dix-huit pays européens.🕒 12:17 · 22 / 10 / 2025 | 📰 Source : partner-feeds.20min.ch


Attention aux antidépresseurs, chacun (ré)agit différemment
Une étude publiée dans «The Lancet» met en garde contre les effets secondaires de ces médicaments, qui peuvent fortement varier d'un patient et d'un produit à l'autre.🕒 12:09 · 22 / 10 / 2025 | 📰 Source : partner-feeds.20min.ch


Une musicienne retrouve l’usage de ses doigts en pleine chirurgie
Le 21 octobre 2025, l’hôpital King’s College de Londres a révélé qu’une patiente atteinte de Parkinson avait joué de la clarinette pendant une opération du cerveau. L’intervention, menée en juillet, a permis à Denise Bacon, 65 ans, de retrouver la mobilité de ses doigts grâce à la stimulation cérébrale profonde. (chs)🕒 11:48 · 22 / 10 / 2025 | 📰 Source : partner-feeds.20min.ch


Cette faute énorme lui vaut un carton rouge historique
Trois minutes de jeu et déjà dehors: João Correia, attaquant de Paphos (Chypre), a été expulsé pour un geste dangereux au visage d’un joueur du Kairat Almaty (Kazakhstan). C’est la deuxième exclusion la plus rapide de l’histoire de la C1. (fch)🕒 11:47 · 22 / 10 / 2025 | 📰 Source : partner-feeds.20min.ch


Une Suissesse de 17 ans a brillé à la Fashion Week de New York
À 16 ans, Mary a remporté un concours de mannequinat à Zurich. Peu de temps après, elle défilait déjà à New York pour deux créateurs. Son parcours parle de lui-même.🕒 11:45 · 22 / 10 / 2025 | 📰 Source : partner-feeds.20min.ch


OpenAI défie Google Chrome avec son propre navigateur dopé à l’IA
L'entreprise de Sam Altman a dévoilé son navigateur ChatGPT Atlas, intégrant l'IA pour transformer l'expérience de navigation.🕒 10:48 · 22 / 10 / 2025 | 📰 Source : partner-feeds.20min.ch


Des millions de lampes illuminent la ville indienne d’Ayodhya
La ville indienne d’Ayodhya a brillé de mille feux à la veille de Diwali, en allumant plus de 2,6 millions de lampes à huile, un record. (atk)🕒 10:03 · 22 / 10 / 2025 | 📰 Source : partner-feeds.20min.ch


Les agriculteurs ne savent plus quoi faire de leurs patates
Des pommes de terre de qualité supérieure sont produites en abondance, mais le manque d'acheteurs se fait sentir.🕒 10:02 · 22 / 10 / 2025 | 📰 Source : partner-feeds.20min.ch


L’Allemagne va payer les employés de l’armée américaine
La paralysie budgétaire aux États-Unis menace les employés en Allemagne des bases américaines.🕒 09:43 · 22 / 10 / 2025 | 📰 Source : partner-feeds.20min.ch


Arrêter de fumer, même tard, réduit les risques de démence
Selon une étude publiée dans «The Lancet», le déclin de la mémoire est ralenti chez les ex-fumeurs, comparé à ceux qui ne renoncent pas au tabagisme.🕒 08:09 · 22 / 10 / 2025 | 📰 Source : partner-feeds.20min.ch


La cryptomonnaie de Melania Trump était-elle une arnaque?
Les architectes de la cryptomonnaie de la première dame des États-Unis sont soupçonnés d'avoir mis sur pied une escroquerie de grande ampleur pour empocher des bénéfices.🕒 07:47 · 22 / 10 / 2025 | 📰 Source : partner-feeds.20min.ch


Pollution, stress, apnée: ces risques négligés qui mènent à l'AVC
Toutes les 30 minutes, une personne fait un AVC en Suisse. Les facteurs de risque sont connus: hypertension, diabète, cholestérol, tabac. Mais ce ne sont pas les seuls.🕒 06:11 · 22 / 10 / 2025 | 📰 Source : partner-feeds.20min.ch


«Je peux gentiment montrer ma vraie facette»
Avec son nouvel EP «Patti Person», la chanteuse Silance casse son image et prend un nouveau départ.🕒 06:09 · 22 / 10 / 2025 | 📰 Source : partner-feeds.20min.ch


L'utilité de prendre un «jour invisible»
Vous vous sentez stressé et submergé par la vie, le travail et les réseaux sociaux? Il est peut-être temps de vous rendre invisible durant une journée.🕒 06:00 · 22 / 10 / 2025 | 📰 Source : partner-feeds.20min.ch


Qui va s'adjuger la guitare mythique de la séparation d'Oasis?
La Gibson rouge sang ne passera pas inaperçue, lors de cette vente organisée à Londres. Elle côtoiera sans complexe les lunettes de Lennon ou celles du King.🕒 20:12 · 21 / 10 / 2025 | 📰 Source : partner-feeds.20min.ch


Des moustiques arrivent pour la première fois en Islande
L'île nordique était l'un des rares territoires habités exempts de ce genre d'insectes, mais ces derniers auraient profité de navires commerciaux pour débarquer.🕒 19:32 · 21 / 10 / 2025 | 📰 Source : partner-feeds.20min.ch


L'algorithme de TikTok pousse-t-il nos ados au suicide?
Amnesty International s'est mis dans la peau d'adolescents de 13 ans et tire la sonnette d'alarme.🕒 16:40 · 21 / 10 / 2025 | 📰 Source : partner-feeds.20min.ch


Liquide vaisselle: à proscrire dans une cafetière italienne
Nettoyer cet appareil avec du liquide vaisselle est vu comme un sacrilège par les amateurs de café. Selon eux, elle ne doit être rincée qu'à l'eau.🕒 16:00 · 21 / 10 / 2025 | 📰 Source : partner-feeds.20min.ch


Pavel Durov prêt à racheter le butin pour le Louvre… d’Abu Dhabi
Le fondateur de la messagerie Telegram a commenté le casse spectaculaire au musée parisien en le présentant comme un symbole du déclin de la France.🕒 15:42 · 21 / 10 / 2025 | 📰 Source : partner-feeds.20min.ch


Comment les agriculteurs peuvent se passer de pesticides
Produire suffisamment de denrées alimentaires sans polluer? En Suisse, le projet HofLabor prouve qu’une agriculture sans pesticides ni engrais chimiques est possible.🕒 11:00 · 21 / 10 / 2025 | 📰 Source : partner-feeds.20min.ch


«Les responsabilités peuvent aller avec les rêves»
Suzane est de retour avec un troisième album. «Millénium» se veut son œuvre la plus intime et la plus engagée à ce jour.🕒 06:16 · 21 / 10 / 2025 | 📰 Source : partner-feeds.20min.ch


Taylor Swift propulse Portofino: hausse de 1329% des recherches
Dans son nouvel album, la chanteuse américaine mentionne la station balnéaire italienne. Depuis, les recherches la concernant ont augmenté de 1329%.🕒 06:00 · 21 / 10 / 2025 | 📰 Source : partner-feeds.20min.ch


«Je ne promets pas de faire rire, je ne sais pas le faire»
Quatre ans après «Kaamelott: premier volet», les hilarantes aventures du roi Arthur reviennent en salle. Le créateur de la saga culte, Alexandre Astier, raconte.🕒 21:32 · 20 / 10 / 2025 | 📰 Source : partner-feeds.20min.ch


WhatsApp serre la vis en limitant les messages aux inconnus
Le service de messagerie tente de résoudre son problème de messages non sollicités en bloquant le nombre d'envois que les utilisateurs ou entreprises peuvent effectuer.🕒 19:21 · 20 / 10 / 2025 | 📰 Source : partner-feeds.20min.ch


Un «Scream Club» permet d’évacuer son stress en hurlant
Le calme habituel qui règne sur la colline d’Hampstead Heath a été troublé par une bande de jeunes décidés à se débarrasser sur place de leur surplus de stress.🕒 16:34 · 20 / 10 / 2025 | 📰 Source : partner-feeds.20min.ch


Voici la bière la plus petite du monde!
Le brasseur danois Carlsberg a créé la plus petite bière du monde pour sensibiliser à la consommation responsable, a-t-il annoncé lundi.🕒 16:11 · 20 / 10 / 2025 | 📰 Source : partner-feeds.20min.ch


Sacs à main de créateurs: un placement inestimable
Ces accessoires de luxe griffés sont des investissements convoités par un nombre croissant de jeunes femmes. Une experte, employée par Sotheby's, nous explique la raison.🕒 16:00 · 20 / 10 / 2025 | 📰 Source : partner-feeds.20min.ch


Meta enterre l'app Messenger sur Mac et Windows
Les utilisateurs du service de messagerie sur ordinateur seront bientôt obligés de migrer vers sa version web.🕒 11:13 · 20 / 10 / 2025 | 📰 Source : partner-feeds.20min.ch


Retour progressif à la normale après une panne mondiale
Une partie d'Internet et des applications au cœur du quotidien de millions de personnes se sont grippés lundi.🕒 10:27 · 20 / 10 / 2025 | 📰 Source : partner-feeds.20min.ch


Ils se tirent les oreilles pour lutter contre le stress
Se pincer le lobe de l'oreille ferait baisser le stress, selon certains thérapeutes. Cette technique de relaxation rapide a en tout cas du succès sur TikTok.🕒 06:00 · 20 / 10 / 2025 | 📰 Source : partner-feeds.20min.ch


Qui est Léa? La candidate suisse qui est entrée au château
Venue de Suisse, Léa fait partie des nouveaux élèves qui ont franchi, samedi soir, les portes du château de Dammarie-lès-Lys.🕒 13:50 · 19 / 10 / 2025 | 📰 Source : partner-feeds.20min.ch


Pour un pain plus sain, congelez-le avant de le griller
Grâce à un processus chimique, le pain congelé puis réchauffé est plus sain et permet d'éviter les pics de glycémie.🕒 08:00 · 19 / 10 / 2025 | 📰 Source : partner-feeds.20min.ch


À quoi sert le petit trou sur la poignée d'un aspirateur?
Vous avez peut-être déjà remarqué l'ouverture située sur la poignée de votre aspirateur. Elle a une fonction bien précise et très utile.🕒 08:00 · 18 / 10 / 2025 | 📰 Source : partner-feeds.20min.ch


Il faudra peut-être bientôt payer pour visiter la Thaïlande
L'instauration d'une taxe touristique suscite le débat depuis des années en Thaïlande. Un nouveau ministre entend désormais la faire appliquer.🕒 16:00 · 17 / 10 / 2025 | 📰 Source : partner-feeds.20min.ch


Le captage du carbone est sous pression
Climeworks, pionnière du captage du CO₂ dans l’air, a subi une série de revers en 2025. Sa technologie incarne-t-elle l’avenir ou s'agit-il d'un simple effet de mode?🕒 11:00 · 17 / 10 / 2025 | 📰 Source : partner-feeds.20min.ch


Le pantalon en daim fait son grand retour
Le pantalon en daim était déjà porté par les icônes de la mode des années 1960. Cette saison, il s'impose comme un incontournable chez les fashionistas.🕒 06:00 · 17 / 10 / 2025 | 📰 Source : partner-feeds.20min.ch


Et si vous débarrassiez de votre peur de déranger?
Il arrive qu'on n'ose pas contacter ses proches par peur de paraître envahissant. Pourtant, une étude démontre que la démarche est plus appréciée qu'on ne le pense.🕒 16:00 · 16 / 10 / 2025 | 📰 Source : partner-feeds.20min.ch


Escapade gourmande en Géorgie durant les vendanges
Ce pays, berceau de la viticulture il y a 8000 ans, se distingue par une cuisine singulière, située au carrefour des influences européenne, turque et iranienne.🕒 06:00 · 16 / 10 / 2025 | 📰 Source : partner-feeds.20min.ch


Trottinette et alcool = retrait de permis?
Conduire une trottinette électrique en état d'ébriété peut coûter plus qu'une amende. À partir d'une certaine d'alcoolémie, on risque un retrait du permis de conduire.🕒 16:00 · 15 / 10 / 2025 | 📰 Source : partner-feeds.20min.ch


Le créateur d'affiches mythiques du cinéma est décédé
Drew Struzan, l’artiste américain derrière les affiches emblématiques de «Star Wars», «Indiana Jones» ou «Retour vers le futur», est mort à l’âge de 78 ans.🕒 11:51 · 15 / 10 / 2025 | 📰 Source : partner-feeds.20min.ch


«Quand j'arrive sur un plateau, je me sens à ma place»
À l'affiche du film «Chien 51», Adèle Exarchopoulos incarne une policière d'élite dans un futur proche et inquiétant. Jouer la comédie la passionne toujours autant.🕒 07:07 · 15 / 10 / 2025 | 📰 Source : partner-feeds.20min.ch


Combien de temps un chien peut-il rester seul?
Les chiens sont des animaux de meute à qui la solitude pèse. Selon une experte canine, ils peuvent rester seuls trois ou quatre heures par jour.🕒 06:00 · 15 / 10 / 2025 | 📰 Source : partner-feeds.20min.ch


Que faire des plantes sur le balcon en octobre?
Il commence à faire froid. Le moment est venu de faire les dernières récoltes et de rentrer certaines plantes.🕒 16:00 · 14 / 10 / 2025 | 📰 Source : partner-feeds.20min.ch


Cette ville britannique méconnue serait la plus belle du monde
Une étude s'est penchée sur le nombre de bâtiments d'une ville pour lesquels le nombre d'or s'applique. L'objectif était de déterminer la plus belle ville du monde.🕒 06:00 · 14 / 10 / 2025 | 📰 Source : partner-feeds.20min.ch


La douche express est-elle vraiment suffisante?
Plusieurs célébrités misent sur des douches de courte durée pour le bien de leur peau et de l'environnement. Bonne ou mauvaise idée? Une dermatologue fait le point.🕒 16:00 · 13 / 10 / 2025 | 📰 Source : partner-feeds.20min.ch


Reconnaissez-vous l’acteur derrière le tueur Ed Gein sur Netflix?
Ce visage de Ed Gein dans Monster vous semble familier ? C’est normal. Sous les traits du célèbre tueur se trouve Charlie Hunnam, l’acteur anglais de 45 ans qu’on a déjà vu dans plusieurs rôles marquants.🕒 13:25 · 13 / 10 / 2025 | 📰 Source : partner-feeds.20min.ch


Comment paraître instantanément plus sympathique
Il existe des astuces pour gagner en popularité auprès de ses collègues. Cela va du choix du siège en salle de réunion à la façon de conclure une conversation.🕒 06:00 · 13 / 10 / 2025 | 📰 Source : partner-feeds.20min.ch


Gagne tes places pour LHC–HC Davos et rencontre un joueur !
Tente de remporter tes billets et un Meet & Greet à la fin du match entre le Lausanne HC et le HC Davos qui aura lieu le 29 octobre à la Vaudoise aréna.🕒 00:01 · 13 / 10 / 2025 | 📰 Source : partner-feeds.20min.ch


De la bonne bagarre comme on l’aime tant
Dans un monde ravagé par la tyrannie et la magie déchue,«Absolum» mêle baston classique en 2D et roguelite, offrant des combats nerveux.🕒 19:52 · 12 / 10 / 2025 | 📰 Source : partner-feeds.20min.ch


Trente ans après, les jeux de combat loin du K.-O.
L’Evo France, plus grand tournoi européen de jeux de baston, a rassemblé des milliers de fans à Nice, confirmant la vitalité d’une scène née dans les salles d’arcade.🕒 17:30 · 12 / 10 / 2025 | 📰 Source : partner-feeds.20min.ch


Test de dépistage positif à cause d'un bagel au pavot?
Si manger un petit pain au pavot n'a pas de quoi inquiéter, il est néanmoins préférable de s'en abstenir avant un test de dépistage.🕒 08:00 · 12 / 10 / 2025 | 📰 Source : partner-feeds.20min.ch


Cette coiffure agit comme une opération de chirurgie esthétique
Le «bleph bun» a le même effet qu'une blépharoplastie. Il ne faut toutefois pas en abuser, au risque de provoquer une chute des cheveux.🕒 08:00 · 11 / 10 / 2025 | 📰 Source : partner-feeds.20min.ch


Prix, autonomie, puissance: la première Ferrari électrique arrive
Alors que le modèle définitif sera présenté début 2026, la marque au cheval cabré a donné des détails sur L’Elettrica, sa première voiture électrique.🕒 11:03 · 09 / 10 / 2025 | 📰 Source : partner-feeds.20min.ch


«Unyielder», des combats de boss de fous furieux
Ce titre indépendant propose une succession de combats de boss intenses et spectaculaires, portés par un gameplay nerveux et une direction artistique exemplaire.🕒 06:13 · 09 / 10 / 2025 | 📰 Source : partner-feeds.20min.ch


Pourquoi l'emplacement de la trappe à carburant varie-t-il?
En fonction des marques et des modèles, la trappe à carburant se trouve tantôt à gauche, tantôt à droite, voire à l'avant. Pourquoi?🕒 06:00 · 09 / 10 / 2025 | 📰 Source : partner-feeds.20min.ch


À partir de quelle température faut-il allumer le chauffage?
Il ne faut pas attendre d'avoir froid pour allumer le chauffage, mais le mettre en route dès que le mercure baisse afin d'éviter les dégâts dus au gel et les moisissures.🕒 16:00 · 07 / 10 / 2025 | 📰 Source : partner-feeds.20min.ch


Record historique à plus de 125'000 dollars pour le bitcoin
Le bitcoin a franchi un nouveau sommet dimanche matin pour atteindre 125'245,57 dollars, un record pour la première cryptomonnaie mondiale.🕒 08:08 · 05 / 10 / 2025 | 📰 Source : partner-feeds.20min.ch


Sur le bitume, Sonic n’a rien à envier à Mario
Grâce à ses portails dimensionnels et ses 39 circuits, «Sonic Racing: CrossWorlds» ose rivaliser avec «Mario Kart».🕒 07:19 · 03 / 10 / 2025 | 📰 Source : partner-feeds.20min.ch


Du trading à la sauce e-sport en Corée du Sud
Un événement inédit, mariant le monde de la finance et des cryptomonnaies à celui des compétitions de jeux vidéo, a fait sensation sur les réseaux sociaux.🕒 18:34 · 30 / 09 / 2025 | 📰 Source : partner-feeds.20min.ch


A-t-on le droit d'accélérer quand une voiture essaie de dépasser?
Si un véhicule veut vous doubler, vous devez lui fournir de l'espace pour lui permettre de vous dépasser et de se rabattre. Vous ne devez jamais accélérer.🕒 16:00 · 25 / 09 / 2025 | 📰 Source : partner-feeds.20min.ch


Chirurgie esthétique: les cinq opérations les plus risquées
La liposuccion, la rhinoplastie, le body contouring, le Brazilian butt lift et la blépharoplastie sont des interventions particulièrement délicates.🕒 06:00 · 12 / 09 / 2025 | 📰 Source : partner-feeds.20min.ch


Le calvaire d'un jeune Vaudois torturé pendant quatre jours
On en sait plus sur le jeune homme séquestré du 28 au 31 août, avant d’être libéré dans un raid de l’unité d’élite de la gendarmerie près de la gare de Valence (F).🕒 22:00 · 05 / 09 / 2025 | 📰 Source : partner-feeds.20min.ch


Tatouage ou grain de beauté?
La dernière tendance en date en matière de tatouages consiste à réaliser des motifs si discrets qu'ils sont à peine visibles à l'œil nu.🕒 06:00 · 03 / 09 / 2025 | 📰 Source : partner-feeds.20min.ch


Résultats et classements des championnats européens
Retrouvez les résultats de chaque journée et les classements des plus grands championnats européens de football.🕒 15:47 · 14 / 02 / 2025 | 📰 Source : partner-feeds.20min.ch


Le système du commerce mondial «risque de dérailler», dit l’ONU
Suivez l'actualité économique en Suisse et dans le monde.🕒 11:21 · 16 / 01 / 2024 | 📰 Source : partner-feeds.20min.ch


«Israël ne doit pas recourir à la famine comme méthode de guerre»
Israël et le Hamas sont parvenus à un accord sur un cessez-le-feu, une étape majeure visant à mettre fin à deux ans de guerre destructrice à Gaza.🕒 10:46 · 16 / 01 / 2024 | 📰 Source : partner-feeds.20min.ch


Zelensky salue les sanctions américaines contre Moscou
Suivez l'actualité du conflit et les tensions entre Moscou et l'Occident depuis le début de la guerre en février 2022.🕒 11:23 · 21 / 01 / 2022 | 📰 Source : partner-feeds.20min.ch


Frayeur au Luna Park: «Le truc, il va tomber! Il s'est cassé!»
L'attraction la plus extrême de l'événement a connu une inquiétante panne, ce week-end. Plus de peur que de mal, l'engin est en réparation cette semaine.🕒 08:00 · 29 / 04 / 2025 | 📰 Source : partner-feeds.20min.ch


Quatre blessés dans une attaque au couteau, un suspect arrêté
L’assaillant a attaqué les clients d'un supermarché et les a poignardés, vendredi 25 octobre. Ses motivations ne sont pas encore connues.🕒 14:32 · 25 / 10 / 2024 | 📰 Source : partner-feeds.20min.ch


Un adolescent de 14 ans tué, son beau-père reconnaît les faits
Le corps du jeune garçon a été retrouvé dans la maison familiale. Le couple a pris la fuite vers la banlieue parisienne.🕒 09:44 · 25 / 10 / 2024 | 📰 Source : partner-feeds.20min.ch


Dernier adieu à Lina, un an après sa disparition
L'adolescente de 15 ans avait disparu dans son village. Ses proches lui rendent hommage ce vendredi 25 octobre, lors de ses funérailles.🕒 08:38 · 25 / 10 / 2024 | 📰 Source : partner-feeds.20min.ch


Trois morts dans une attaque au couteau à Shanghai
Un homme a tué trois personnes lors d’une attaque au couteau dans un supermarché de Shanghai, lundi soir. 15 autres personnes sont blessées.🕒 05:48 · 01 / 10 / 2024 | 📰 Source : partner-feeds.20min.ch


Un homme arrêté à Rome pour un double meurtre commis en 1977
La police australienne a annoncé samedi l’arrestation à Rome, en Italie, d’un homme pour le meurtre de deux femmes survenu en 1977 à Melbourne.🕒 06:52 · 21 / 09 / 2024 | 📰 Source : partner-feeds.20min.ch


Saisie de près d’une tonne de cocaïne en Uruguay
La police uruguayenne a annoncé la saisie de près d’une tonne de cocaïne, d’une valeur de plus de 28 millions de francs, dans la région de la capitale Montevideo.🕒 05:41 · 21 / 09 / 2024 | 📰 Source : partner-feeds.20min.ch


Chasse à l’homme après une fusillade
Un homme est activement recherché par les autorités après avoir blessé cinq personnes en tirant près d’une autoroute, samedi dans l’État du Kentucky.🕒 04:53 · 08 / 09 / 2024 | 📰 Source : partner-feeds.20min.ch


Un directeur de prison assassiné en Équateur
Le directeur d’une prison équatorienne a été tué mardi dans une attaque contre son véhicule dans le nord-est du pays. Deux autres agents ont été blessés.🕒 06:35 · 04 / 09 / 2024 | 📰 Source : partner-feeds.20min.ch


Un bus scolaire percute des piétons en Chine, au moins 11 morts
Pour une raison encore inconnue, un bus scolaire a percuté des piétons devant l’entrée d’un collège mardi en Chine, faisant au moins 11 morts.🕒 06:30 · 03 / 09 / 2024 | 📰 Source : partner-feeds.20min.ch


Le nouveau patron de Starbucks pourra se rendre au travail en jet
Désireux de rester vivre en Californie, le nouveau patron de Strabucks aura le droit d’emprunter le jet de la société pour se rendre au siège du groupe à Seattle.🕒 04:52 · 23 / 08 / 2024 | 📰 Source : partner-feeds.20min.ch


L’incendie d’un hôtel fait sept morts
Un incendie d’origine inconnue a fait sept morts et douze blessés vendredi dans un hôtel de Bucheon, une ville proche de Séoul.🕒 03:17 · 23 / 08 / 2024 | 📰 Source : partner-feeds.20min.ch


Deux condamnés à mort exécutés dans l’Utah et au Texas
Le Texas a procédé mercredi soir à l'exécution d’un condamné à mort, alors qu’une autre a eu lieu jeudi, dans l’Utah.🕒 06:40 · 08 / 08 / 2024 | 📰 Source : partner-feeds.20min.ch


Un journaliste qui était sous protection policière assassiné
Placé sous protection policière, Alejandro Martinez Noguez a été assassiné par balle dimanche au Mexique alors qu’il se déplaçait en voiture avec ses gardes du corps.🕒 03:20 · 05 / 08 / 2024 | 📰 Source : partner-feeds.20min.ch


Deux membres d’un club de motards tués par balles
Deux hommes, âgés de 30 et 38 ans, ont été retrouvés morts dans la nuit de samedi à dimanche dans le nord de la France.🕒 20:05 · 04 / 08 / 2024 | 📰 Source : partner-feeds.20min.ch


Un homme tué à coups de couteau, son frère arrêté
Un homme a été tué à coups de couteau, dimanche dans le département français de la Seine-et-Marne. Son frère a été arrêté et placé en garde à vue.🕒 23:39 · 28 / 07 / 2024 | 📰 Source : partner-feeds.20min.ch


La famille royale britannique cherche à réduire son bilan carbone
La famille royale britannique a dévoilé mercredi ses projets pour parvenir à «la neutralité carbone» à l’avenir.🕒 01:21 · 24 / 07 / 2024 | 📰 Source : partner-feeds.20min.ch


Les corridas seront interdites en Colombie dès 2027
Promulguée par le président Gustavo Petro lundi, une loi va mettre fin aux corridas en Colombie à partir de 2027, après une période «transitoire».🕒 06:38 · 23 / 07 / 2024 | 📰 Source : partner-feeds.20min.ch


Deux morts dans un probable règlement de comptes à Paris
Deux personnes ont été tuées dans un probable règlement de comptes lié au trafic de drogue vendredi soir en région parisienne.🕒 00:33 · 20 / 07 / 2024 | 📰 Source : partner-feeds.20min.ch


Une enquête ouverte après l’abattage illégal de 65 kangourous
Un refuge de l’État de Victoria a découvert les dépouilles d’au moins 65 kangourous, tués par balle ou apparemment percutés par un véhicule.🕒 06:49 · 11 / 07 / 2024 | 📰 Source : partner-feeds.20min.ch


Après 36h en mer, une nageuse retrouvée à 80 km des côtes
Une Japonaise a dérivé pendant 36 heures en mer avant d’être retrouvée vivante en mer, à environ 80 kilomètres de la plage où elle avait commencé à nager.🕒 05:52 · 11 / 07 / 2024 | 📰 Source : partner-feeds.20min.ch


Potentiellement «attaqué par un crocodile», un ado porté disparu
Un adolescent de 12 ans est porté disparu après une baignade dans une crique dans une région reculée du nord de l’Australie.🕒 05:52 · 03 / 07 / 2024 | 📰 Source : partner-feeds.20min.ch


Quatre morts dans une fusillade entre police et narcotrafiquants
Un policier et trois narcotrafiquants présumés sont décédés dimanche lors d’un affrontement dans l’État de Tamaulipas, au nord-est du Mexique.🕒 06:38 · 24 / 06 / 2024 | 📰 Source : partner-feeds.20min.ch


Ils tuent le gardien mais n'arrivent pas à charger le coffre-fort
Des malfrats ont voulu cambrioler un hôtel parisien. Ils ont tué le veilleur de nuit mais ont abandonné le coffre-fort dans la rue.🕒 12:13 · 22 / 06 / 2024 | 📰 Source : partner-feeds.20min.ch


16’000 bouchers amateurs se sont blessés lors de l’Aïd en Turquie
En 2023, près de 30’000 personnes avaient été blessées au cours des quatre jours de célébrations de l’Aïd el-Kebir, en Turquie, selon le bilan officiel.🕒 22:21 · 16 / 06 / 2024 | 📰 Source : partner-feeds.20min.ch


Rare naissance d’éléphants jumeaux
Une éléphante a donné naissance à des jumeaux lors d’un accouchement mouvementé dans un centre en Thaïlande, blessant au passage un soigneur.🕒 06:23 · 11 / 06 / 2024 | 📰 Source : partner-feeds.20min.ch


Une ado trébuche et se tue lors d'une balade en famille
Une Américaine de 16 ans a fait une chute mortelle ce dimanche, alors qu'elle se promenait dans la région des Gorges Mystérieuses.🕒 14:31 · 10 / 06 / 2024 | 📰 Source : partner-feeds.20min.ch


Huit morts dans des combats entre dissidents des FARC
Des affrontements ont opposé durant le week-end deux factions rivales au sein des dissidents des FARC, dans le sud de la Colombie.🕒 05:27 · 27 / 05 / 2024 | 📰 Source : partner-feeds.20min.ch


Dix morts et 40 blessés dans un accident d’autocar en Turquie
Un autocar a dévié de sa trajectoire puis percuté deux voitures et un camion venant en sens inverse, dimanche sur une autoroute du sud de la Turquie.🕒 22:58 · 26 / 05 / 2024 | 📰 Source : partner-feeds.20min.ch


Huit personnes tuées lors d’une attaque armée près de Mexico
Une fusillade a fait au moins huit morts ce samedi dans une ville de l’État central mexicain de Morelos, près de Mexico.🕒 23:58 · 12 / 05 / 2024 | 📰 Source : partner-feeds.20min.ch


La nouvelle vie mouvementée du suspect de l'affaire Maddie
Libéré en septembre, l'Allemand Christian Brückner vit désormais dans la rue, dans le nord de l'Allemagne.🕒 11:19 · 23 / 10 / 2025 | 📰 Source : partner-feeds.20min.ch


Mis en examen à 13 ans après le viol filmé d’un garçon de 9 ans
Un adolescent a été mis en examen après avoir filmé un viol sur un enfant de 9 ans par un autre petit garçon.🕒 11:09 · 23 / 10 / 2025 | 📰 Source : partner-feeds.20min.ch


Trump manque-t-il vraiment de «courage et d'intégrité»?
Les propos attribués au président du comité Nobel affirmant que «courage et intégrité» manquaient à Donald Trump sont faux. Ils ont été déformés. (fch)🕒 10:01 · 23 / 10 / 2025 | 📰 Source : partner-feeds.20min.ch


«Il était en train de coucher avec ma mère»
En Pennsylvanie, un homme de 55 ans aurait été abattu par le fils de sa nouvelle compagne, furieux de les avoir surpris en plein acte sexuel.🕒 10:00 · 23 / 10 / 2025 | 📰 Source : partner-feeds.20min.ch


La police de l’immigration de Trump dépense sans compter
Alors que d’autres agences gouvernementales fonctionnent au ralenti en raison de la fermeture partielle de l’administration, l’ICE est largement épargnée.🕒 09:16 · 23 / 10 / 2025 | 📰 Source : partner-feeds.20min.ch


En soins intensifs après des injections illégales de Botox
Des cas graves de botulisme ont été signalés en France après des injections illégales de toxine botulinique, par des personnes «non habilitées».🕒 08:53 · 23 / 10 / 2025 | 📰 Source : partner-feeds.20min.ch


Les soins capillaires lissants, passeport pour le cancer?
Certains de ces produits contiennent un composé chimique qui fait exploser le risque de cancer du pancréas ou de la thyroïde, alerte une étude américaine.🕒 08:17 · 23 / 10 / 2025 | 📰 Source : partner-feeds.20min.ch


Le cycliste français emprisonné en Russie a été libéré
Accusé de «franchissement illégal de la frontière» russe, il avait été arrêté début septembre.🕒 07:52 · 23 / 10 / 2025 | 📰 Source : partner-feeds.20min.ch


Les États-Unis détruisent un bateau dans le Pacifique
Les États-Unis ont visé un bateau, tuant trois personnes dans le Pacifique, dans ce qu'ils présentent comme une frappe contre des narcotrafiquants, selon la Défense.🕒 07:41 · 23 / 10 / 2025 | 📰 Source : partner-feeds.20min.ch


«Xi Jinping peut avoir une grande influence sur Poutine»
C'est ce qu'a déclaré Donald Trump aux journalistes, lors d’une rencontre avec le secrétaire général de l’OTAN, Mark Rutte, dans le Bureau ovale de la Maison-Blanche.🕒 07:06 · 23 / 10 / 2025 | 📰 Source : partner-feeds.20min.ch


Lola a dit: «Madame, s’il vous plaît, ne me faites pas de mal»
L'accusée a livré un témoignage peu en rapport avec les conclusions des médecins légistes. Son mobile n'apparaît guère plus clair.🕒 21:44 · 22 / 10 / 2025 | 📰 Source : partner-feeds.20min.ch


Meurtre d'une ado: il la tue parce qu'elle voulait le plaquer
Âgé de 20 ans, le compagnon de la victime a été mis en examen pour homicide volontaire par conjoint et placé en détention provisoire.🕒 19:54 · 22 / 10 / 2025 | 📰 Source : partner-feeds.20min.ch


Un dérivé enrichi de la vitamine K pourrait inverser l'Alzheimer
Des chercheurs japonais ont créé un nouveau composé pour aider les cellules cérébrales immatures à se développer en neurones.🕒 19:28 · 22 / 10 / 2025 | 📰 Source : partner-feeds.20min.ch


Trois détenus en garde à vue après des menaces envers Sarkozy
Une vidéo, dans laquelle on entend des cris et insultes visant l'ancien président, circulait mercredi sur les réseaux sociaux.🕒 19:08 · 22 / 10 / 2025 | 📰 Source : partner-feeds.20min.ch


La cheffe écolo Marine Tondelier sort du bois pour 2027
L'élue du Pas-de-Calais a emboîté le pas à Clémentine Autain et François Ruffin dans le cadre d'une primaire de la gauche, que refusent LFI et Place publique.🕒 19:03 · 22 / 10 / 2025 | 📰 Source : partner-feeds.20min.ch


La surveillance vidéo extérieure est «très insuffisante»
La directrice du musée parisien a exprimé sa «blessure» suite au braquage des bijoux de la couronne. Elle a aussi évoqué la vétusté des moyens de surveillance.🕒 18:28 · 22 / 10 / 2025 | 📰 Source : partner-feeds.20min.ch


Une guerre directe «dans trois, quatre ans» face à la Russie?
L’armée française doit être «prête à un choc dans trois, quatre ans» face à la Russie, a affirmé mercredi le chef d’état-major des armées français.🕒 17:05 · 22 / 10 / 2025 | 📰 Source : partner-feeds.20min.ch


«Faites que cette chose soit enfermée toute sa vie»
La mère de la victime, en pleurs, a évoqué sa fille et réclamé la peine maximale contre une accusée qu'elle a qualifiée de «chose» ou de «diable».🕒 16:09 · 22 / 10 / 2025 | 📰 Source : partner-feeds.20min.ch


Accusé d’avoir une Rolex, ce député de gauche dévoile la vérité
Louis Boyard, filmé en train d’enlever une prétendue montre de luxe avant de passer à la télé à l’Assemblée, a réagi dans une vidéo et dénonce une campagne de désinformation. (fch)🕒 15:34 · 22 / 10 / 2025 | 📰 Source : partner-feeds.20min.ch


Des milliers de jeunes Ukrainiens émigrent en Allemagne
Kiev a récemment assoupli sa loi en autorisant les jeunes adultes de sexe masculin à quitter le pays.🕒 14:28 · 22 / 10 / 2025 | 📰 Source : partner-feeds.20min.ch


Le Prix Sakharov pour deux journalistes emprisonnés
Andrzej Poczobut et Mzia Amaghlobeli, en prison en Biélorussie et en Géorgie, ont reçu jeudi le prix décerné par le Parlement européen.🕒 14:09 · 22 / 10 / 2025 | 📰 Source : partner-feeds.20min.ch


Ils auraient séquestré une femme dans un garage pendant cinq ans
Deux personnes ont été mises en examen pour la «séquestration avec torture ou actes de barbarie» d'une femme de 45 ans, a annoncé le parquet de Nantes.🕒 12:32 · 22 / 10 / 2025 | 📰 Source : partner-feeds.20min.ch


Les mineurs arrêtés étaient en fait majeurs
Trois individus ont été interpellés dimanche, à Annemasse, (F) à bord d’un véhicule volé. Ils étaient soi-disant âgés de 16 et 17 ans. Ce n’était pas le cas.🕒 11:27 · 22 / 10 / 2025 | 📰 Source : partner-feeds.20min.ch


Le roi Charles III va prier avec le pape au Vatican
Le souverain britannique va se rendre au Vatican, 64 ans après la première visite de sa mère Elizabeth II.🕒 10:42 · 22 / 10 / 2025 | 📰 Source : partner-feeds.20min.ch


L’Allemagne va payer les employés de l’armée américaine
La paralysie budgétaire aux États-Unis menace les employés en Allemagne des bases américaines.🕒 09:43 · 22 / 10 / 2025 | 📰 Source : partner-feeds.20min.ch


L’époux de la Première ministre veut être un «mari discret»
Le mari de la nouvelle Première ministre japonaise, un ancien élu du Parlement, veut soutenir son épouse mais rester «discret».🕒 09:15 · 22 / 10 / 2025 | 📰 Source : partner-feeds.20min.ch


Deux agents protègent Sarkozy des «menaces qui pèsent sur lui»
Deux officiers de sécurité vont accompagner la détention de l'ancien président français, a annoncé mercredi le ministre de l’Intérieur, Laurent Nunez.🕒 08:32 · 22 / 10 / 2025 | 📰 Source : partner-feeds.20min.ch


Jusqu’à 17 ans de prison pour des collaborateurs de Bolsonaro
Un policier et cinq militaires, ainsi que le président d’un institut indépendant de sondage électoral, ont été condamnés.🕒 08:24 · 22 / 10 / 2025 | 📰 Source : partner-feeds.20min.ch


Donald Trump veut revenir au WEF de Davos
Le président américain Donald Trump compte bien se rendre à nouveau au Forum économique mondial de Davos, en 2026.🕒 08:05 · 22 / 10 / 2025 | 📰 Source : partner-feeds.20min.ch


Affaire Grégory: Jacqueline Jacob va-t-elle enfin parler?
La grand-tante du petit garçon assassiné en 1984 serait l'auteure de la lettre de revendication du crime. Elle doit être entendue par la justice vendredi, à Dijon.🕒 06:58 · 22 / 10 / 2025 | 📰 Source : partner-feeds.20min.ch


La Corée du Nord a tiré un missile balistique
Ce projectile «non identifié» a été tiré mercredi en direction de l’est, d’après l’état-major interarmées sud-coréen.🕒 06:52 · 22 / 10 / 2025 | 📰 Source : partner-feeds.20min.ch


La patronne du Louvre en première ligne après le casse du siècle
Laurence des Cars doit s’exprimer, mercredi, devant des parlementaires français pour expliquer comment des cambrioleurs ont pu voler des joyaux de la couronne.🕒 06:48 · 22 / 10 / 2025 | 📰 Source : partner-feeds.20min.ch


Les critiques sur sa salle de bal? Trump n'en a cure
Sans surprise, Donald Trump a balayé mardi les critiques entourant la démolition d’une partie de la Maison-Blanche pour construire une vaste salle de bal.🕒 06:41 · 22 / 10 / 2025 | 📰 Source : partner-feeds.20min.ch


«Tu es le plus fort des papas»: le message de Giulia à son père
La petite dernière du clan Sarkozy était sous le feu des projecteurs ce mardi matin, au moment où son père a été incarcéré.🕒 21:44 · 21 / 10 / 2025 | 📰 Source : partner-feeds.20min.ch


Un préjudice évalué à 88 millions d'euros
La crainte de la conservatrice du Louvre est que les voleurs fassent fondre les bijoux pour mieux les écouler, ce qui réduirait, cependant, considérablement leur valeur.🕒 21:41 · 21 / 10 / 2025 | 📰 Source : partner-feeds.20min.ch


Expulsé de chez lui à 76 ans, il se suicide devant l'huissier
L'homme s'est mortellement blessé malgré l'intervention de la police présente sur place. La mesure avait été décidée pour «dette de loyer».🕒 21:11 · 21 / 10 / 2025 | 📰 Source : partner-feeds.20min.ch


Les musées suisses se distinguent sur un point des français
Un coup comme celui du Louvre ne peut être exclu dans nos musées, mais une différence notable les rend moins vulnérables que ceux de France, selon un historien de l'art.🕒 20:41 · 21 / 10 / 2025 | 📰 Source : partner-feeds.20min.ch


Sa technique pour tuer un cafard vire au drame, sa voisine décède
Une Sud-Coréenne a imaginé un lance-flammes artisanal pour tuer un cafard. Un incendie s'est déclenché et une voisine a perdu la vie en tombant du cinquième étage.🕒 19:37 · 21 / 10 / 2025 | 📰 Source : partner-feeds.20min.ch


Le mystère du Boeing percuté à 10’000 mètres d’altitude est levé
Un avion de United Airlines avait dû se poser en urgence le 16 octobre, après être entré en collision avec un objet non identifié. Ce n'était pas un débris spatial.🕒 17:49 · 21 / 10 / 2025 | 📰 Source : partner-feeds.20min.ch


L'ONU condamne «les actions secrètes et les menaces» américaines
Les experts des Nations Unies estiment qu'actuellement les États-Unis «violent la souveraineté du Venezuela» et mettent en garde contre une «escalade» dangereuse.🕒 16:32 · 21 / 10 / 2025 | 📰 Source : partner-feeds.20min.ch


Pavel Durov prêt à racheter le butin pour le Louvre… d’Abu Dhabi
Le fondateur de la messagerie Telegram a commenté le casse spectaculaire au musée parisien en le présentant comme un symbole du déclin de la France.🕒 15:42 · 21 / 10 / 2025 | 📰 Source : partner-feeds.20min.ch


Un bus des TPG percuté par un train de marchandises
Un accident s’est produit lundi à un passage à niveau situé à Saint-Julien (F). Il n’y a aucun blessé à déplorer.🕒 15:25 · 21 / 10 / 2025 | 📰 Source : partner-feeds.20min.ch


Près d'une personne sur deux dit souffrir de douleurs chroniques
Selon le baromètre de la fondation Analgesia, les douleurs les plus fréquentes sont celles du dos et des membres supérieurs, de la tête et du ventre.🕒 15:11 · 21 / 10 / 2025 | 📰 Source : partner-feeds.20min.ch


Les salariés américains d'Allemagne pourraient ne plus être payés
La paralysie budgétaire aux États-Unis menace désormais les employés en Allemagne des bases américaines de Ramstein et Kaiserslautern.🕒 14:54 · 21 / 10 / 2025 | 📰 Source : partner-feeds.20min.ch


Sarkozy restera en prison au minimum «trois semaines ou un mois»
Incarcéré mardi, l'ex-président a fait une demande de remise en liberté.🕒 13:24 · 21 / 10 / 2025 | 📰 Source : partner-feeds.20min.ch


La lutte contre la malaria est au point mort, dénoncent des ONG
Changement climatique, croissance démographique et financement insuffisant figurent parmi les facteurs qui menacent de faire repartir cette maladie.🕒 12:42 · 21 / 10 / 2025 | 📰 Source : partner-feeds.20min.ch


«Sans arrestation en 48h, les pièces auront sans doute disparu»
Qu’adviendra-t-il des bijoux volés au musée du Louvre? Le cambriolage fait le tour du monde et les médias sollicitent tous les experts, qui livrent chacun leur pronostic.🕒 12:12 · 21 / 10 / 2025 | 📰 Source : partner-feeds.20min.ch


21 ans de prison pour l'homme qui a blessé le Premier ministre
Juraj Cintula avait grièvement blessé par balle le Premier ministre nationaliste Robert Fico en mai 2024.🕒 11:00 · 21 / 10 / 2025 | 📰 Source : partner-feeds.20min.ch


Nicolas Sarkozy a savouré ses derniers jours de liberté
Avant d'être emprisonné, ce mardi, l'ancien président français a fêté en famille l'anniversaire de sa fille dans l'hôtel de luxe Four Seasons George V.🕒 10:39 · 21 / 10 / 2025 | 📰 Source : partner-feeds.20min.ch


«Y'a Sarkozy!» s'exclament les détenus à son arrivée à la prison
L'ancien président français a été incarcéré mardi, à la prison parisienne de La Santé, une première historique dans l'histoire de la République.🕒 09:37 · 21 / 10 / 2025 | 📰 Source : partner-feeds.20min.ch


Alerte enlèvement levée, le petit Rayan de retour dans son foyer
L'enfant enlevé lundi soir en Haute-Vienne a été retrouvé et placé dans un foyer spécialisé, a annoncé l'AFP.🕒 09:16 · 21 / 10 / 2025 | 📰 Source : partner-feeds.20min.ch


Un maire assassiné dans la rue dans le centre du Mexique
Le maire de la ville de Pisaflores a été abattu en pleine rue par plusieurs hommes armés, a annoncé, mardi, la police locale.🕒 08:54 · 21 / 10 / 2025 | 📰 Source : partner-feeds.20min.ch


Tornade destructrice: grues effondrées, un mort et quatre blessés
Une tornade soudaine a frappé Ermont, au nord de Paris, faisant un mort et quatre blessés graves après l’effondrement de trois grues sur un chantier.🕒 08:28 · 21 / 10 / 2025 | 📰 Source : partner-feeds.20min.ch


Voici la première femme Première ministre du Japon
La nomination de la conservatrice de 64 ans, sera officielle après sa rencontre avec l’empereur Naruhito.🕒 07:49 · 21 / 10 / 2025 | 📰 Source : partner-feeds.20min.ch


Il y a une «dépendance excessive à l’égard d’un seul fournisseur»
Un grand nombre de services en ligne d’entreprises et d'autres applications connues ont connu des perturbations, voire des interruptions totales lundi.🕒 07:42 · 21 / 10 / 2025 | 📰 Source : partner-feeds.20min.ch


Mémoires posthumes de la principale accusatrice du prince Andrew
C'est ce mardi que paraissent les mémoires ravageurs de Virginia Giuffre pour le prince Andrew. Elle l'accuse d’agressions sexuelles dans le cadre de l’affaire Epstein.🕒 06:46 · 21 / 10 / 2025 | 📰 Source : partner-feeds.20min.ch


Prison pour un violeur qui avait simulé sa mort pour s'enfuir
Nicholas Rossi a tenté d’échapper à la justice en simulant sa mort pour s’enfuir en Ecosse. Il a été condamné à au moins cinq ans de prison, lundi.🕒 06:42 · 21 / 10 / 2025 | 📰 Source : partner-feeds.20min.ch


Nicolas Sarkozy entre en prison ce mardi matin
L'ancien président, condamné à cinq ans ferme, se rendra ce matin à la prison de la Santé pour y purger sa peine.🕒 06:38 · 21 / 10 / 2025 | 📰 Source : partner-feeds.20min.ch


Maison-Blanche: Trump rase une aile pour bâtir une salle de bal
Le président étasunien a détruit une partie de l'édifice pour construire sa future gigantesque salle de bal.🕒 06:34 · 21 / 10 / 2025 | 📰 Source : partner-feeds.20min.ch


Justice: Trump autorisé à déployer la Garde nationale à Portland
Une cour d’appel a estimé lundi que le président a le pouvoir de déployer la Garde nationale dans la ville démocrate de l’ouest du pays.🕒 06:30 · 21 / 10 / 2025 | 📰 Source : partner-feeds.20min.ch


«On a du mal à imaginer que le corps de Lola rentrait là-dedans»
Les témoignages de témoins directs ont permis de retracer la journée d'errance de la suspecte après son meurtre présumé.🕒 21:25 · 20 / 10 / 2025 | 📰 Source : partner-feeds.20min.ch


«Nous avions une bombe à retardement entre les mains»
Le Bureau d’enquête sur les accidents a conclu qu'un câble du funiculaire n'était pas aux normes. Il recommande aussi que les autres ascenseurs restent à l’arrêt.🕒 20:21 · 20 / 10 / 2025 | 📰 Source : partner-feeds.20min.ch


L'enfer du prince Andrew ne ferait que commencer
Buckingham se prépare à voir émerger de nouvelles accusations contre le frère de Charles III à la suite de la parution des mémoires posthumes d'une de ses accusatrices.🕒 18:15 · 20 / 10 / 2025 | 📰 Source : partner-feeds.20min.ch


Rien ne va plus entre les Etats-Unis et la Colombie
La Colombie a rappelé son ambassadeur à Washington après les menaces de Trump. Lequel a évoqué une possible intervention militaire.🕒 16:48 · 20 / 10 / 2025 | 📰 Source : partner-feeds.20min.ch


Le Japon autorise la pilule du lendemain sans ordonnance
Le contraceptif d'urgence sera en vente libre, sans aucune restriction d’âge et aucune obligation de consentement parental pour les femmes concernées.🕒 15:47 · 20 / 10 / 2025 | 📰 Source : partner-feeds.20min.ch


Ado morte dans un hôtel: des «hurlements pendant des heures»
Une jeune fille, qui pourrait avoir 15 ans, a été retrouvée sans vie dans un hôtel près de Lille, lundi matin. Des témoins disent avoir entendu des cris vers 4h.🕒 15:47 · 20 / 10 / 2025 | 📰 Source : partner-feeds.20min.ch


Avant d'aller en prison, Sarkozy a été reçu par Macron
Il était «normal» de recevoir Nicolas Sarkozy «sur le plan humain» avant son incarcération, estime le président français.🕒 15:35 · 20 / 10 / 2025 | 📰 Source : partner-feeds.20min.ch


Près de la moitié des cadres RH sont des frontaliers
Selon les derniers chiffres franco-suisses, 45% des postes de responsable des ressources humaines sont occupés par des frontaliers.🕒 15:02 · 20 / 10 / 2025 | 📰 Source : partner-feeds.20min.ch


Vol des bijoux du Louvre: huit minutes d’un casse spectaculaire
Comment les cambrioleurs du musée parisien ont-ils pu dérober des joyaux de la Couronne avec tant de facilité? Retour sur le braquage.🕒 14:25 · 20 / 10 / 2025 | 📰 Source : partner-feeds.20min.ch


L’interdiction des achats de gaz russe franchit une étape clé
La majorité des États membres ont approuvé lundi l’interdiction d’importer du gaz naturel russe dans l’Union européenne d’ici fin 2027.🕒 13:51 · 20 / 10 / 2025 | 📰 Source : partner-feeds.20min.ch


Donald Trump «rêve» s'il pense avoir détruit les sites nucléaires
Le guide suprême iranien Ali Khamenei a laissé entendre que les sites nucléaires iraniens n'avaient pas été détruits par les attaques israélo-américaines du mois de juin.🕒 13:41 · 20 / 10 / 2025 | 📰 Source : partner-feeds.20min.ch


Trump traite le président colombien de «baron de la drogue»
Le président américain, Donald Trump, a accusé Gustavo Petro de «ne rien faire pour arrêter» le trafic de drogue et annoncé suspendre des aides financières à la Colombie.🕒 13:02 · 20 / 10 / 2025 | 📰 Source : partner-feeds.20min.ch


Les œuvres du Louvre ne sont pas assez surveillées
La Cour des comptes estime que le plus grand musée du monde accuse un «retard persistant» dans le domaine de la protection des œuvres.🕒 12:08 · 20 / 10 / 2025 | 📰 Source : partner-feeds.20min.ch


Les 27 s’apprêtent à interdire l’importation du gaz russe
Une fois approuvée par les 27, la mesure devra encore être négociée avec le Parlement européen.🕒 11:18 · 20 / 10 / 2025 | 📰 Source : partner-feeds.20min.ch


La rencontre Trump-Zelensky a dégénéré: «Poutine va te détruire»
Donald Trump a reçu Volodymyr Zelensky, vendredi, à la Maison-Blanche. Une rencontre qui aurait de nouveau dégénéré, comme le rapportent certains médias américains.🕒 10:13 · 20 / 10 / 2025 | 📰 Source : partner-feeds.20min.ch


Les Houthis détiennent 20 employés de l’ONU
Les rebelles yéménites ont arrêté des employés de l'ONU qu'ils accusent d'espionnage au profit des États-Unis et d’Israël, selon un haut responsable houthi.🕒 10:04 · 20 / 10 / 2025 | 📰 Source : partner-feeds.20min.ch


Darmanin ira voir Sarkozy en prison: «Je suis triste pour lui»
Le ministre français de la Justice a indiqué qu'il se rendrait à la Santé pour s'assurer des conditions de sécurité de l'ex-président.🕒 09:45 · 20 / 10 / 2025 | 📰 Source : partner-feeds.20min.ch


Un véhicule de police touché par un obus lors d'une démonstration
Un rarissime accident s'est produit samedi lors d'une démonstration militaire des Marines en Californie, à l'occasion du 250e anniversaire des Marines.🕒 09:20 · 20 / 10 / 2025 | 📰 Source : partner-feeds.20min.ch


Quatre morts dans l'incendie d'un immeuble de dix étages à Lyon
Quatre personnes ont péri dans l'incendie d'un immeuble de dix étages, qui s'est déclaré lundi matin, dans le IIIe arrondissement de Lyon.🕒 08:36 · 20 / 10 / 2025 | 📰 Source : partner-feeds.20min.ch


Comment Giorgia Meloni a stabilisé l'économie italienne
Le gouvernement de la dirigeante d'extrême droite affiche un bilan économique assez flatteur, après trois ans aux commandes.🕒 08:07 · 20 / 10 / 2025 | 📰 Source : partner-feeds.20min.ch


Dernier jour de liberté: Sarkozy est-il prêt à dormir en prison ?
L'ancien président français, condamné à cinq ans de prison, va entrer dans l'histoire, mardi, en devenant le premier président à connaître la détention.🕒 07:35 · 20 / 10 / 2025 | 📰 Source : partner-feeds.20min.ch


Un avion-cargo quitte la piste à Hong Kong: deux morts
L'avion de transport de fret a heurté lundi un véhicule au sol lors de son atterrissage, avant de sortir de la piste et de s’abîmer en mer.🕒 06:55 · 20 / 10 / 2025 | 📰 Source : partner-feeds.20min.ch


Traque des cambrioleurs «chevronnés» du casse éclair en 7 minutes
En pleine matinée dominicale, quatre cambrioleurs ont dérobé huit joyaux de la Couronne au musée du Louvre, à Paris, lors d’une opération éclair.🕒 06:51 · 20 / 10 / 2025 | 📰 Source : partner-feeds.20min.ch


Une oeuvre de Picasso disparaît pendant un transfert
Le tableau «Nature morte à la guitare» de Pablo Picasso, estimé à 600’000 euros, s’est volatilisé lors de son transfert de Madrid à Grenade. L’œuvre, qui devait être exposée à la Fondation Caja Granada, n’est jamais arrivée à destination. Une enquête a été ouverte, tandis que l’organisation du transport est vivement critiquée pour une escale nocturne jugée inutile.🕒 06:07 · 20 / 10 / 2025 | 📰 Source : partner-feeds.20min.ch


Donald Trump menace désormais San Francisco
Après l'envoi de militaires à Los Angeles, Washington et Memphis, le président américain a affirmé dimanche que la ville californienne serait la prochaine sur la liste.🕒 22:20 · 19 / 10 / 2025 | 📰 Source : partner-feeds.20min.ch


Décès de celle qui a œuvré pour la criminalisation du viol
Monique Pelletier, ancienne ministre française de la Condition féminine et des Familles, s'est éteinte dimanche à l'âge de 99 ans.🕒 20:57 · 19 / 10 / 2025 | 📰 Source : partner-feeds.20min.ch


La manœuvre folle de la police: «J'ai failli perdre la vie»
Une vidéo largement relayée sur les réseaux sociaux montre une voiture de police française manquer de faire tomber un motard, sur l'autoroute.🕒 20:30 · 19 / 10 / 2025 | 📰 Source : partner-feeds.20min.ch


Des centaines de personnes ont manifesté pour la Palestine
Les manifestants espèrent que l'ONU prendra des mesures afin que la responsabilité des multinationales dans la situation à Gaza soit reconnue et sanctionnée.🕒 18:47 · 19 / 10 / 2025 | 📰 Source : partner-feeds.20min.ch


Les Boliviens élisent leur futur président
Les citoyens se sont rendus aux urnes dimanche, pour choisir entre deux candidats de droite. Les résultats sont attendus dans la nuit.🕒 18:04 · 19 / 10 / 2025 | 📰 Source : partner-feeds.20min.ch


Vingt employés de l'ONU détenus dont le chef de l'Unicef
Des forces de sécurité houties ont pénétré sans autorisation sur le site de l'ONU à Sanaa et ont emprisonné 20 employés, dont quinze étrangers.🕒 16:32 · 19 / 10 / 2025 | 📰 Source : partner-feeds.20min.ch


Combats de chiens illégaux: la police retrouve des cadavres
Les forces de l'ordre ont fait irruption sur un site de combats de chiens illégaux, dans la nuit de samedi à dimanche, et ont arrêté quatorze personnes.🕒 15:24 · 19 / 10 / 2025 | 📰 Source : partner-feeds.20min.ch


Léon XIV proclame sept nouveaux saints, dont trois religieuses
Le pape Léon XIV a célébré la canonisation de sept saints, marquant un moment fort pour l'Église catholique.🕒 14:33 · 19 / 10 / 2025 | 📰 Source : partner-feeds.20min.ch


Des millions de gens ont manifesté contre lui, Trump se moque
En réaction aux manifestations «No Kings», où des millions de personnes sont descendues dans la rue samedi, Trump a publié des vidéos générées par IA le montrant en roi.🕒 13:38 · 19 / 10 / 2025 | 📰 Source : partner-feeds.20min.ch


Voici le butin à plusieurs millions des voleurs du Louvre
Les inconnus qui ont pénétré dimanche dans le Louvre avaient pour cible la galerie d'Apollon. Leur butin date de l'époque napoléonienne et vaut des millions.🕒 13:37 · 19 / 10 / 2025 | 📰 Source : partner-feeds.20min.ch


Un soldat nord-coréen a franchi la frontière vers la Corée du Sud
Dimanche, un soldat nord-coréen a fait défection vers la Corée du Sud, traversant la dangereuse zone démilitarisée.🕒 12:32 · 19 / 10 / 2025 | 📰 Source : partner-feeds.20min.ch


Retailleau juge «invotable en l'état» le projet de budget
Reconduit comme Premier ministre le 10 octobre, Sébastien Lecornu est déjà menacé de censure.🕒 12:05 · 04 / 12 / 2024 | 📰 Source : partner-feeds.20min.ch


Vents violents près de Paris: un mort, quatre blessés très graves
Canicules, incendies, intempéries, tsunamis, séismes, éruptions… Suivez l'actu météo et les catastrophes naturelles à l'international.🕒 11:36 · 16 / 01 / 2024 | 📰 Source : partner-feeds.20min.ch


«Israël ne doit pas recourir à la famine comme méthode de guerre»
Israël et le Hamas sont parvenus à un accord sur un cessez-le-feu, une étape majeure visant à mettre fin à deux ans de guerre destructrice à Gaza.🕒 10:46 · 16 / 01 / 2024 | 📰 Source : partner-feeds.20min.ch


Zelensky salue les sanctions américaines contre Moscou
Suivez l'actualité du conflit et les tensions entre Moscou et l'Occident depuis le début de la guerre en février 2022.🕒 11:23 · 21 / 01 / 2022 | 📰 Source : partner-feeds.20min.ch


Décos de Noël éteintes pendant la nuit: la polémique enfle
Le canton du Valais souhaite lutter contre la pollution lumineuse publique et privée entre minuit et 6h du matin. À peine envisagé, le projet fait déjà des remous.🕒 10:00 · 23 / 10 / 2025 | 📰 Source : partner-feeds.20min.ch


Ligne haute tension au sol, chutes d'arbres: il y a des dégâts
La première tempête automnale frappe la Suisse avec des vents violents. Une pointe à 131 km/h a été mesurée aux Diablerets.🕒 08:15 · 23 / 10 / 2025 | 📰 Source : partner-feeds.20min.ch


Il tente tout pour déduire des barres protéinées de ses impôts
Un Bernois qui se rend au travail à vélo s'est battu, en vain, pour pouvoir soustraire de sa déclaration d'impôts près de 3400 fr. de frais liés à son mode de transport.🕒 08:10 · 23 / 10 / 2025 | 📰 Source : partner-feeds.20min.ch


Une résidence envahie par les caddies empruntés à Coop
Dans un quartier argovien, les chariots débordent depuis que Coop, qui a reçu de nouveaux caddies, ne récupère plus les anciens que les clients ramenaient chez eux.🕒 06:01 · 23 / 10 / 2025 | 📰 Source : partner-feeds.20min.ch


De plus en plus d'animaux abandonnés arrivent dans les refuges
La Protection suisse des animaux a révélé que 32'079 animaux ont été recueillis en 2024. Un chiffre qui a tendance à augmenter.🕒 22:35 · 22 / 10 / 2025 | 📰 Source : partner-feeds.20min.ch


Éruptions cutanées à La Poste: colis chinois suspectés
Des employés du centre de colis à Frauenfeld ont signalé des problèmes de peau. La Suva n'a rien trouvé d'anormal mais deux élues insistent pour que l'on creuse.🕒 16:58 · 22 / 10 / 2025 | 📰 Source : partner-feeds.20min.ch


Les requérants d'asile ne pourront plus voyager à l'étranger
Désormais, les personnes relevant de l’asile ne pourront plus voyager à l’étranger, sauf exception. Les Ukrainiens sous statut S ne sont pas concernés par cette mesure.🕒 14:54 · 22 / 10 / 2025 | 📰 Source : partner-feeds.20min.ch


Collision mortelle entre une voiture et un camion à Muttenz
Une conductrice de 76 ans a perdu la vie mardi après-midi dans le canton de Bâle-Campagne. Elle a dévié de sa trajectoire et percuté un camion de plein fouet.🕒 14:16 · 22 / 10 / 2025 | 📰 Source : partner-feeds.20min.ch


Un couple se fait voler ses plaques de voiture en Espagne
En vacances à Valence, ces Suisses ont eu la mauvaise surprise de découvrir leur véhicule sans plaques d'immatriculation. Le cas n'est pas rare, selon un assureur.🕒 13:40 · 22 / 10 / 2025 | 📰 Source : partner-feeds.20min.ch


Les robotaxis de Baidu débarquent en Suisse en décembre
Le géant chinois commencera les essais de ses taxis autonomes dans trois cantons, en partenariat avec CarPostal, à la fin de l'année.🕒 13:39 · 22 / 10 / 2025 | 📰 Source : partner-feeds.20min.ch


Une Suissesse de 17 ans a brillé à la Fashion Week de New York
À 16 ans, Mary a remporté un concours de mannequinat à Zurich. Peu de temps après, elle défilait déjà à New York pour deux créateurs. Son parcours parle de lui-même.🕒 11:45 · 22 / 10 / 2025 | 📰 Source : partner-feeds.20min.ch


Il réveille ses soldats en leur balançant un chat à la figure
Dans une caserne de Lenzburg (AG), un sergent aurait, en pleine nuit, lancé un chat sur des soldats endormis. L’armée condamne ce comportement.🕒 11:44 · 22 / 10 / 2025 | 📰 Source : partner-feeds.20min.ch


Les agriculteurs ne savent plus quoi faire de leurs patates
Des pommes de terre de qualité supérieure sont produites en abondance, mais le manque d'acheteurs se fait sentir.🕒 10:02 · 22 / 10 / 2025 | 📰 Source : partner-feeds.20min.ch


Une violente tempête va toucher la Suisse dès jeudi
La première tempête automnale frappera notre pays cette fin de semaine. Et elle sera puissante, avec des rafales à 120-150 km/h sur les crêtes du Jura et des Préalpes.🕒 08:09 · 22 / 10 / 2025 | 📰 Source : partner-feeds.20min.ch


Collecte textile: le modèle croule sous la fast fashion
Chaque personne en Suisse jette près de sept kilos de textiles chaque année. Les entreprises de collecte atteignent leurs limites, mais des solutions sont en discussion.🕒 08:07 · 22 / 10 / 2025 | 📰 Source : partner-feeds.20min.ch


Donald Trump veut revenir au WEF de Davos
Le président américain Donald Trump compte bien se rendre à nouveau au Forum économique mondial de Davos, en 2026.🕒 08:05 · 22 / 10 / 2025 | 📰 Source : partner-feeds.20min.ch


Les Verts veulent plafonner les salaires des patrons de caisses
Certains patrons touchent un million de francs par an. Pour le parti, emmené par la conseillère nationale vaudoise, Sophie Michaud Gigon, c'est bien trop.🕒 06:06 · 22 / 10 / 2025 | 📰 Source : partner-feeds.20min.ch


Les musées suisses se distinguent sur un point des français
Un coup comme celui du Louvre ne peut être exclu dans nos musées, mais une différence notable les rend moins vulnérables que ceux de France, selon un historien de l'art.🕒 20:41 · 21 / 10 / 2025 | 📰 Source : partner-feeds.20min.ch


Presque tous les élus en Suisse sont victimes d’hostilités
Une étude mandatée par le DFJP révèle que les actes hostiles envers les élus, surtout les femmes et les minorités, sont fréquents à tous les échelons politiques.🕒 19:07 · 21 / 10 / 2025 | 📰 Source : partner-feeds.20min.ch


Des stars bâloises veulent bannir les trams du centre-ville
Les célèbres architectes Herzog & de Meuron ainsi que des personnalités locales vont lancer une initiative pour rendre le centre de Bâle plus sûr et agréable à vivre.🕒 17:49 · 21 / 10 / 2025 | 📰 Source : partner-feeds.20min.ch


Team raclette et compote-graben, voici nos habitudes alimentaires
Une enquête mandatée par l'entreprise Too Good To Go révèle ce que l'on met dans nos assiettes. Et il y a des différences entre Romands et Alémaniques.🕒 16:17 · 21 / 10 / 2025 | 📰 Source : partner-feeds.20min.ch


Suicide assisté: un levier pour le don d’organes?
Si les organes étaient donnés après un suicide assisté, le nombre de dons pourrait potentiellement doubler en Suisse. Mais des questions éthiques se posent.🕒 11:31 · 21 / 10 / 2025 | 📰 Source : partner-feeds.20min.ch


Face aux drones, l’Europe s’alarme, la Suisse relativise
Plusieurs pays de l'UE sont confrontés à des survols mystérieux de drones. En Suisse aussi, les signalements se multiplient, mais les autorités relativisent.🕒 21:19 · 20 / 10 / 2025 | 📰 Source : partner-feeds.20min.ch


Les Romands sortent couverts au sauna, les Alémaniques y vont nus
Un sondage révèle un véritable Röstigraben de la transpiration: les Alémaniques prisent la nudité tandis que les Romands aiment conserver leur maillot de bain.🕒 18:41 · 20 / 10 / 2025 | 📰 Source : partner-feeds.20min.ch


Des radars italiens pour surveiller le ciel suisse
Pour moderniser et «mieux assurer la souveraineté de l'espace aérien inférieur», armasuisse a fait l'acquisition d'un système de radars transalpin.🕒 16:58 · 20 / 10 / 2025 | 📰 Source : partner-feeds.20min.ch


L’assiette magique pour manger sainement, selon la Confédération
Après une pyramide alimentaire controversée l'an dernier, Berne propose désormais une assiette équilibrée qui fournit un apport optimal en énergie et nutriments.🕒 14:39 · 20 / 10 / 2025 | 📰 Source : partner-feeds.20min.ch


Les Alpes perdent jusqu'à 8 cm d'or blanc tous les dix ans
Un nouveau modèle développé par le SLF montre pour la première fois les tendances d’enneigement en Suisse. Les hauteurs moyennes de neige diminuent depuis 60 ans.🕒 14:18 · 20 / 10 / 2025 | 📰 Source : partner-feeds.20min.ch


Un Suisse arrêté sur un catamaran après 26 ans de cavale
Les autorités italiennes ont attrapé un homme de 60 ans à Bari (I). Il était recherché depuis 1999 par les États-Unis pour une fraude à plus de 20 millions de dollars.🕒 14:00 · 20 / 10 / 2025 | 📰 Source : partner-feeds.20min.ch


Chauffeurs Uber en grève: «On ne peut pas survivre avec ces prix»
Entre 800 et 1000 chauffeurs VTC manifestent, lundi matin. Ils réclament des tarifs minimums plus élevés et craignent la concurrence.🕒 13:16 · 20 / 10 / 2025 | 📰 Source : partner-feeds.20min.ch


C'est «KKS» qui devrait gérer La Poste, selon Avenir Suisse
Le think tank libéral propose que le géant jaune soit repris par le DFF de Karin Keller-Sutter et de vendre CarPostal et PostFinance. Des propositions qui passent mal.🕒 10:49 · 20 / 10 / 2025 | 📰 Source : partner-feeds.20min.ch


Immunité levée pour un diplomate exploiteur
Un diplomate pakistanais établi en Suisse est accusé d'avoir exploité ses employés domestiques. Il peut être poursuivi, a décidé le Tribunal fédéral.🕒 08:44 · 20 / 10 / 2025 | 📰 Source : partner-feeds.20min.ch


La controversée Pegasos aide les Anglais à mourir en Suisse
Des familles britanniques accusent l’association, basée à Soleure, d’avoir aidé leurs proches à mourir sans motif médical grave, selon un reportage de la RTS.🕒 08:02 · 20 / 10 / 2025 | 📰 Source : partner-feeds.20min.ch


Un véhicule sur dix circule sans avoir passé l'expertise
Les contrôles techniques obligatoires sur les véhicules prennent toujours plus de retard en Suisse. La Confédération a demandé aux cantons concernés d'agir.🕒 06:03 · 20 / 10 / 2025 | 📰 Source : partner-feeds.20min.ch


Le nombre de réfugiés atteint un niveau historique
Dans de nombreux cantons, la situation est tendue en raison du grand nombre de réfugiés. Les représentants cantonaux appellent le conseiller fédéral Beat Jans à agir.🕒 21:29 · 19 / 10 / 2025 | 📰 Source : partner-feeds.20min.ch


À Flumserberg, on fête l’automne à dos de vache
Dimanche, une nouvelle édition de cette course insolite et réservée aux femmes a réuni plusieurs milliers de spectateurs dans cette station des Alpes.🕒 19:50 · 19 / 10 / 2025 | 📰 Source : partner-feeds.20min.ch


Coup d'arrêt pour une salle de sport estampillée «halal»
Un fitness où les femmes peuvent s'entraîner seules et où on sert de la nourriture halal devait ouvrir lundi à Dietikon. Mais tout n'a pas été réglé administrativement.🕒 18:55 · 19 / 10 / 2025 | 📰 Source : partner-feeds.20min.ch


Collision mortelle entre un motard et une voiture dans un col
Dimanche matin, une collision frontale entre une moto et une voiture a eu lieu sur la route du col du Brünig, à Meiringen. Le motard est décédé sur place.🕒 18:13 · 19 / 10 / 2025 | 📰 Source : partner-feeds.20min.ch


Le chauffeur d'un autocar circulait sans permis et sans visa
Un Serbe de 35 ans a été condamné pour avoir conduit un autocar à travers la Suisse sans permis de conduire, sans visa et sans autorisation de travailler.🕒 16:24 · 19 / 10 / 2025 | 📰 Source : partner-feeds.20min.ch


Une forte proportion de femmes dans les émeutes à Berne
Lors de la violente manifestation propalestinienne à Berne il y a une semaine, près de la moitié des personnes interpellées par la police étaient des femmes.🕒 15:48 · 19 / 10 / 2025 | 📰 Source : partner-feeds.20min.ch


Un motard chute dans le Rhin et perd la vie
Un motocycliste de 84 ans est sorti de la route samedi à Birsfelden. Il a terminé sa course dans le Rhin.🕒 11:46 · 19 / 10 / 2025 | 📰 Source : partner-feeds.20min.ch


L’abonnement demi-tarif reste, et deviendra même meilleur marché
Un article a suscité l’indignation des voyageurs en affirmant que l’abonnement demi-tarif allait être supprimé. Non, affirme le directeur général d'Alliance SwissPass.🕒 10:45 · 19 / 10 / 2025 | 📰 Source : partner-feeds.20min.ch


Dès lundi, il vous faudra un parapluie
Dimanche commencera sous le brouillard sur le Plateau avant un après-midi plus dégagé, tandis qu’un début de semaine contrasté apportera de la pluie.🕒 07:11 · 19 / 10 / 2025 | 📰 Source : partner-feeds.20min.ch


Un bûcheron écrasé par un arbre qu’il venait d’abattre
L’homme travaillait seul en forêt lorsqu’un tronc d’arbre abattu lui est tombé dessus. Il est décédé sur place.🕒 21:33 · 18 / 10 / 2025 | 📰 Source : partner-feeds.20min.ch


Le rapport d'Albert Rösti sur l'avenir des transports agace
Une expertise sur le développement des transports jusqu'en 2045, commandée à l'EPFZ par Albert Rösti, suscite la controverse.🕒 21:18 · 18 / 10 / 2025 | 📰 Source : partner-feeds.20min.ch


Certificat médical dès le premier jour: les médecins saturent
Toujours davantage d'employeurs exigent un certificat médical dès le premier jour d'absence de l'employé. Le système de santé en fait les frais.🕒 18:27 · 18 / 10 / 2025 | 📰 Source : partner-feeds.20min.ch


Les délégués du PLR favorables aux nouveaux accords avec l'UE
Réunis à Berne samedi, le parti a entamé un vaste débat sur les accords qui devront lier la Suisse et l'Union européenne à l'avenir. Le PLR a aussi élu un duo à sa tête.🕒 15:05 · 18 / 10 / 2025 | 📰 Source : partner-feeds.20min.ch


Des génériques dix fois plus chers en Suisse qu'en France
Certains médicaments génériques sont nettement plus chers en Suisse qu'à l'étranger. Des solutions existeraient, mais les autorités peinent à agir.🕒 13:27 · 18 / 10 / 2025 | 📰 Source : partner-feeds.20min.ch


Vingt-cinq demandes de soutien financier ont déjà été approuvées
La commission créée pour attribuer les fonds récoltés après la destruction du village a approuvé des demandes totalisant 1,4 million de francs.🕒 11:57 · 18 / 10 / 2025 | 📰 Source : partner-feeds.20min.ch


Twint et e-banking: tous les services UBS fonctionnent à nouveau
Samedi matin, UBS a connu d’importants dysfonctionnements dans le traitement des paiements, désormais résolus.🕒 11:55 · 18 / 10 / 2025 | 📰 Source : partner-feeds.20min.ch


Une collision frontale fait deux morts à Attiswil
Une voiture et un minibus se sont percutés de plein fouet vendredi en fin d'après-midi à Attiswil. Deux personnes sont décédées sur place.🕒 11:13 · 18 / 10 / 2025 | 📰 Source : partner-feeds.20min.ch


L’air suisse a dépassé les limites d’ozone partout en 2024
Le rapport annuel de l’OFEV révèle des dépassements d’ozone dans tout le pays. Mais la tendance reste positive: l’air suisse est bien plus propre qu’il y a trente ans.🕒 10:07 · 18 / 10 / 2025 | 📰 Source : partner-feeds.20min.ch


Agression à la gare centrale: un blessé et un suspect arrêté
Un homme a roué de coups un passant vendredi vers midi à la gare de Zurich. La victime a été gravement blessée. L'auteur de l'agression a immédiatement été appréhendé.🕒 09:47 · 18 / 10 / 2025 | 📰 Source : partner-feeds.20min.ch


Gris en bas, bleu en haut et c'est pas fini
Du brouillard en plaine pour du soleil en montagne, l'inversion météorologique de ces derniers jours devrait persister ce week-end.🕒 18:15 · 17 / 10 / 2025 | 📰 Source : partner-feeds.20min.ch


Traite d’êtres humains: 90 victimes et une suspecte arrêtée
Une Chinoise de 50 ans est accusée d’avoir recruté et exploité près d'une centaine de femmes en Suisse. La police a bouclé une enquête internationale tentaculaire.🕒 16:49 · 17 / 10 / 2025 | 📰 Source : partner-feeds.20min.ch


Contrebande: arrêtés avec de l'alcool, de la viande et du caviar
Deux camionnettes immatriculées en Ukraine ont été interceptées à Novazzano. Les douaniers ont découvert plus de 7 kg de caviar non déclarés.🕒 16:38 · 17 / 10 / 2025 | 📰 Source : partner-feeds.20min.ch


Un nonagénaire sans lunettes provoque un accident: permis retiré
Jeudi, un homme de 94 ans a percuté une voiture en conduisant sans lunettes, entraînant des blessures et des dommages matériels.🕒 15:13 · 17 / 10 / 2025 | 📰 Source : partner-feeds.20min.ch


Jumbo rappelle des coffrets à jouets
En raison de la présence de substances nocives, l’enseigne de bricolage retire de son assortiment plusieurs modèles de boîtes en tissu Pico Mundo.🕒 14:36 · 17 / 10 / 2025 | 📰 Source : partner-feeds.20min.ch


Une collision frontale dans un tunnel fait deux blessés
Deux voitures sont percutées jeudi soir dans le tunnel de Zollhaus, à Sachseln. Les deux conducteurs ont été blessés et conduits à l’hôpital.🕒 12:41 · 17 / 10 / 2025 | 📰 Source : partner-feeds.20min.ch


«Quand les concierges étaient sur place, ils anticipaient»
Des hotlines, des systèmes de tickets ou encore des services à distance ont remplacé les anciens concierges dans de nombreux locatifs.🕒 08:53 · 17 / 10 / 2025 | 📰 Source : partner-feeds.20min.ch


Délai record pour obtenir son titre de médecin spécialiste
Plus de 2500 médecins suisses attendent depuis près d'un an la validation officielle de leur spécialisation, dont l'octroi traîne. Un collectif monte au créneau.🕒 06:14 · 17 / 10 / 2025 | 📰 Source : partner-feeds.20min.ch


Ces hôtels proposent un abo annuel pour 3333 francs
En janvier, Daniel Renggli lançait un abonnement hivernal pour son dernier hôtel. Il étend maintenant cette offre inédite à l’année. Mais des conditions s'appliquent.🕒 22:22 · 16 / 10 / 2025 | 📰 Source : partner-feeds.20min.ch


L’UDC réclame le retour des explosifs sous les ponts et routes
Jusqu’en 2014, les ouvrages stratégiques du pays pouvaient être détruits en cas d’invasion. L’abandon de ce système dissuasif serait une erreur, selon le parti agrarien.🕒 20:43 · 16 / 10 / 2025 | 📰 Source : partner-feeds.20min.ch


Il y a toujours plus de véhicules à moteur sur les routes suisses
Fin septembre, plus de 6,5 millions de véhicules – surtout des voitures – étaient autorisés à circuler dans notre pays. Un chiffre en hausse par rapport à 2024.🕒 20:20 · 16 / 10 / 2025 | 📰 Source : partner-feeds.20min.ch


RoadCross veut interdire aux jeunes de conduire des bolides
La fondation RoadCross voudrait que les jeunes conducteurs ne puissent plus piloter des voitures puissantes. Une telle idée avait déjà échoué devant le Parlement en 2022.🕒 19:51 · 16 / 10 / 2025 | 📰 Source : partner-feeds.20min.ch


Saint-Gall: deux enfants blessés par des bovins en fuite
Trois petits ruminants se sont échappés, mercredi, de la foire agricole OLMA, renversant un garçon de six ans et écrasant le pied d'une fillette.🕒 16:51 · 16 / 10 / 2025 | 📰 Source : partner-feeds.20min.ch


Spray contre les overdoses d'opioïdes disponible sans ordonnance
Dès le 1er novembre, l'accès au naloxone sera facilité en pharmacie. Genève prévoit de former des policiers et des intervenants sociaux à l'utilisation de cet antidote.🕒 15:41 · 16 / 10 / 2025 | 📰 Source : partner-feeds.20min.ch


Chocs entre animaux et voitures: une facture toujours plus salée
Le nombre d'accidents recensés par l'assurance AXA reste stable en Suisse, mais les coûts engendrés par les collisions prennent l'ascenseur.🕒 15:24 · 16 / 10 / 2025 | 📰 Source : partner-feeds.20min.ch


Les négociations dans la construction au point mort, grève en vue
Les syndicats Unia et Syna annoncent que les employés de la construction soutiennent des mouvements de grève pour obtenir de meilleures conditions de travail.🕒 14:46 · 16 / 10 / 2025 | 📰 Source : partner-feeds.20min.ch


Un maître doit se séparer de son chien considéré comme un molosse
Pendant des années, le propriétaire zurichois d'un animal croisé s'est battu pour le conserver. Le TF a tranché: le chien, qui a trop du Amstaff, devra quitter le canton.🕒 13:43 · 16 / 10 / 2025 | 📰 Source : partner-feeds.20min.ch


Conseiller d'Etat impliqué dans un accident: policiers acquittés
Deux gendarmes étaient soupçonnés d'avoir favorisé le conseiller d'Etat tessinois Norman Gobbi, lors d'un accident de la route. La justice les a blanchis.🕒 11:28 · 16 / 10 / 2025 | 📰 Source : partner-feeds.20min.ch


Une cornée imprimée en 3D pour recouvrer la vue sans donneur
Une équipe internationale, à laquelle participe l'Université de Zurich, développe un implant autocollant qui pourrait remplacer la greffe de cornée issue d'un don.🕒 10:11 · 16 / 10 / 2025 | 📰 Source : partner-feeds.20min.ch


Il attaque une famille parce qu'il l'entend parler ukrainien
Dans un train, un homme russophone a agressé une famille d'origine ukrainienne. Il l'a menacée de mort et s'est montré violent.🕒 08:52 · 16 / 10 / 2025 | 📰 Source : partner-feeds.20min.ch


Les riches qui menaçaient de quitter la Suisse sont toujours là
De grandes fortunes ont promis de quitter la Suisse avant la votation sur l'imposition de l'héritage dès 50 millions. A 90 jours du scrutin, ils n'ont pas bougé.🕒 06:02 · 16 / 10 / 2025 | 📰 Source : partner-feeds.20min.ch


Berne estime inutile la lutte contre les certificats complaisants
Le Conseil fédéral estime qu'il est rare que des médecins délivrent des certificats de complaisance. Pour lui, le droit actuel est suffisant pour contrer le phénomène.🕒 22:55 · 15 / 10 / 2025 | 📰 Source : partner-feeds.20min.ch


De la viande de requin toxique finit en douce dans nos assiettes
Des organisations alertent sur des taux élevés de méthylmercure dans la viande de requin. Problème: ces produits sont souvent vendus sous d'autres appellations.🕒 22:25 · 15 / 10 / 2025 | 📰 Source : partner-feeds.20min.ch


Voici ce que les droits de douane à 39% rapportent aux États-Unis
Washington impose désormais 39% de droits de douane sur les produits suisses. Tech, montres et café sont les premières victimes de ces surtaxes.🕒 20:39 · 15 / 10 / 2025 | 📰 Source : partner-feeds.20min.ch


Des PFAS détectés jusqu’au sommet du Cervin
Ces polluants éternels s’accumulent non seulement dans le corps humain, mais aussi dans l’environnement. Une étude montre que même les Alpes sont touchées.🕒 18:53 · 15 / 10 / 2025 | 📰 Source : partner-feeds.20min.ch


Un vol de... fontaine d’alpage!
La police cherche des témoins après la disparition d’un bassin de 200 kilos dans les hauteurs de Mädris-Vermol.🕒 17:21 · 15 / 10 / 2025 | 📰 Source : partner-feeds.20min.ch


Une randonneuse perd la vie dans la région de Brienz
Une femme partie en randonnée, lundi, a été retrouvée sans vie mardi, au nord de Brienz.🕒 16:25 · 15 / 10 / 2025 | 📰 Source : partner-feeds.20min.ch


Viol près d'une gare: la police recherche des témoins
Une femme a indiqué avoir été violée par un inconnu, lundi soir, à Näfels. Elle avait été abordée par son agresseur peu de temps avant dans le train.🕒 15:18 · 15 / 10 / 2025 | 📰 Source : partner-feeds.20min.ch


Alerte en cas de danger: Berne mise désormais sur les SMS
Le Conseil fédéral met en consultation une stratégie multicanal pour prévenir les Suisses en cas de danger. Tous les portables devraient recevoir des messages d'alerte.🕒 14:22 · 15 / 10 / 2025 | 📰 Source : partner-feeds.20min.ch


Ils cambriolent une armurerie et se font pincer
Deux voleurs venus de France sont entrés par effraction dans un magasin d'armes à Dintikon durant la nuit. La police a réussi à les arrêter peu de temps après.🕒 14:20 · 15 / 10 / 2025 | 📰 Source : partner-feeds.20min.ch


Les réserves de gaz assurées pendant encore trois hivers
Le Conseil fédéral a décidé de continuer de constituer des réserves de gaz jusqu'en 2028 pour éviter les pénuries.🕒 13:53 · 15 / 10 / 2025 | 📰 Source : partner-feeds.20min.ch


La FINMA fait appel de la décision du TAF sur les obligations AT1
L’Autorité fédérale de surveillance des marchés financiers conteste le jugement du Tribunal administratif fédéral et fera recours devant le Tribunal fédéral.🕒 12:03 · 15 / 10 / 2025 | 📰 Source : partner-feeds.20min.ch


Une initiative veut permettre aux animaux de rente de sortir
Un comité veut que les vaches, poules ou cochons aient accès librement à l'extérieur. Il prépare une initiative populaire qui sera lancée le printemps prochain.🕒 11:19 · 15 / 10 / 2025 | 📰 Source : partner-feeds.20min.ch


L'abo demi-tarif va-t-il disparaître? L'Alliance SwissPass dément
Le très populaire abonnement serait sur la sellette et pourrait être supprimé avec l'introduction du système «My Ride» en 2027, selon K-Tipp. L'Alliance SwissPass dément.🕒 09:30 · 15 / 10 / 2025 | 📰 Source : partner-feeds.20min.ch


Aldi déclenche la guerre des prix autour de la livre de pain
Tous les grands détaillants baissent leurs tarifs depuis que le discounter vend son mi-blanc à 99 centimes. Les boulangers-confiseurs suisses sont inquiets.🕒 08:20 · 15 / 10 / 2025 | 📰 Source : partner-feeds.20min.ch


Une épave plus vieille que le Titanic enfouie... en Suisse?
Une épave située à 114 mètres dans les profondeurs du lac des Quatre-Cantons pourrait être plus ancienne que le Titanic. Son origine reste un mystère pour les chercheurs suisses. (Vidéo: Lea Hafen)🕒 06:05 · 15 / 10 / 2025 | 📰 Source : partner-feeds.20min.ch


Sondage 20Min/Tamedia: l'impôt sur les successions serait balayé
L'initiative de la Jeunesse socialiste qui veut imposer les successions ne convainc que 31% des sondés. L'initiative «Service citoyen» serait acceptée de justesse.🕒 06:04 · 15 / 10 / 2025 | 📰 Source : partner-feeds.20min.ch


Un avis mortuaire aurait mis des voleurs sur la piste de bijoux
Des cambrioleurs ont dérobé pour 250'000 francs de bijoux à Zoug. L'adresse d'une habitante décédée a été publiée par les autorités.🕒 22:16 · 14 / 10 / 2025 | 📰 Source : partner-feeds.20min.ch


La clientèle se tourne davantage vers les produits étrangers
La pression sur les prix et de nouvelles préférences ont bouleversé les rayons alimentaires en deux décennies. Même les produits typiquement suisses sont concernés.🕒 19:32 · 14 / 10 / 2025 | 📰 Source : partner-feeds.20min.ch


Assister à la naissance en direct même lors d'une césarienne
D'ordinaire, se trouvant derrière un drap vert, les parents ne voient pas leur enfant naître en cas de césarienne. Un hôpital zurichois a trouvé la solution.🕒 18:47 · 14 / 10 / 2025 | 📰 Source : partner-feeds.20min.ch


Les Suisses vont bientôt pouvoir admirer deux comètes
Le ciel nocturne offre ce mois-ci un spectacle rare avec l’apparition simultanée de deux comètes, Lemmon et Swan. La première sera visible à l'œil nu d'ici peu.🕒 17:12 · 14 / 10 / 2025 | 📰 Source : partner-feeds.20min.ch


«Il était aussi au téléphone!»: une scène hallucinante à Zurich
Au milieu du tunnel du Gubrist, un homme a roulé à trottinette électrique tout en «utilisant son téléphone», d’après un lecteur-reporter. La police est intervenue, mais il avait déjà disparu. (fch)🕒 17:02 · 14 / 10 / 2025 | 📰 Source : partner-feeds.20min.ch


Une initiative veut reconnaître l’État de Palestine
Lassés d’attendre un geste du Conseil fédéral, des acteurs de la société civile lancent une initiative pour que la Suisse reconnaisse la Palestine comme État indépendant.🕒 15:34 · 14 / 10 / 2025 | 📰 Source : partner-feeds.20min.ch


Les douaniers découvrent un collier à 80'000 fr. sous le siège
Lors d’un contrôle au poste-frontière de Bâle, les agents ont découvert un bijou serti de 97 diamants caché sous le siège d'une voiture conduite par un Luxembourgeois.🕒 15:19 · 14 / 10 / 2025 | 📰 Source : partner-feeds.20min.ch


Un élu UDC exige une interdiction nationale du voile
Après la diffusion de photos de jeunes filles voilées dans des mosquées suisses, le Saint-Gallois Mike Egger réclame une interdiction nationale du foulard islamique.🕒 12:13 · 14 / 10 / 2025 | 📰 Source : partner-feeds.20min.ch


Karin Keller-Sutter a perdu son frère
Walter Sutter, frère de la présidente de la Confédération, est décédé la semaine dernière à 75 ans. Karin Keller-Sutter n'ira dès lors pas à Washington cette semaine.🕒 09:19 · 14 / 10 / 2025 | 📰 Source : partner-feeds.20min.ch


La Suisse craint une nouvelle guerre mondiale
Les tensions géopolitiques inquiètent la population suisse, mais toutefois moins que les autres pays européens. Le climat reste le risque numéro un à l'échelle mondiale.🕒 08:32 · 14 / 10 / 2025 | 📰 Source : partner-feeds.20min.ch


Nouvelles règles dans le cadre du transfert de Moutier
Deux nouveaux accords liés au transfert de Moutier ont été signés par les cantons de Berne et du Jura. Le premier, sur la police, entre en vigueur le 15 novembre.🕒 10:32 · 23 / 10 / 2025 | 📰 Source : partner-feeds.20min.ch


Revue et Cirque de Noël se disputent la Plaine de Plainpalais
Le spectacle satirique devrait s’installer sur l’espace à partir de 2026. Mais le Cirque a saisi la justice.🕒 10:13 · 23 / 10 / 2025 | 📰 Source : partner-feeds.20min.ch


Décos de Noël éteintes pendant la nuit: la polémique enfle
Le canton du Valais souhaite lutter contre la pollution lumineuse publique et privée entre minuit et 6h du matin. À peine envisagé, le projet fait déjà des remous.🕒 10:00 · 23 / 10 / 2025 | 📰 Source : partner-feeds.20min.ch


Ligne haute tension au sol, chutes d'arbres: il y a des dégâts
La première tempête automnale frappe la Suisse avec des vents violents. Une pointe à 131 km/h a été mesurée aux Diablerets.🕒 08:15 · 23 / 10 / 2025 | 📰 Source : partner-feeds.20min.ch


Adel des 2be3: «On était trois amis avant d'être un boys band»
La série «Culte–2Be3» sort le 24 octobre sur Prime Video. Membre du trio, Adel Kachermi, qui travaille à Genève dans la conciergerie de luxe, revient sur cette aventure.🕒 08:11 · 23 / 10 / 2025 | 📰 Source : partner-feeds.20min.ch


Crise entre assureurs et médecins: les patients en paient le prix
De nombreux assurés se voient refuser le remboursement de certains frais médicaux par leur complémentaire, car leur médecin n'a pas adhéré à un système tarifaire précis.🕒 20:42 · 22 / 10 / 2025 | 📰 Source : partner-feeds.20min.ch


Coq trop bruyant: la commune exige que la famille s'en débarrasse
Des habitants se sont plaints de nuisances causées par le coq d'un poulailler familial. Ses propriétaires ont été sommés de s'en séparer, mais ils refusent.🕒 20:39 · 22 / 10 / 2025 | 📰 Source : partner-feeds.20min.ch


Cette vidéo virale suscite de l'inquiétude et agace en Suisse
La vidéo de Magnus Midtbø escaladant seul le Cervin cartonne sur les réseaux. Les secouristes s’inquiètent des risques et des possibles imitations. (fch)🕒 20:34 · 22 / 10 / 2025 | 📰 Source : partner-feeds.20min.ch


Le boom des prothèses capillaires: «Ça a changé ma vie!»
De plus en plus d'hommes et de femmes ont recours aux prothèses capillaires, malgré un tabou tenace. La tendance se répand sur les réseaux comme une traînée de poudre.🕒 18:10 · 22 / 10 / 2025 | 📰 Source : partner-feeds.20min.ch


Condamné pour viol, il faisait office de famille d'accueil
Deux hommes, ayant eu des démêlés avec la justice il y a plusieurs décennies, étaient inscrits dans le dispositif de familles d'accueil.🕒 15:30 · 22 / 10 / 2025 | 📰 Source : partner-feeds.20min.ch


Le Jet d’eau mis à l’arrêt pendant cinq semaines
Le symbole genevois doit faire l’objet de travaux de maintenance, à partir de la semaine prochaine.🕒 12:50 · 22 / 10 / 2025 | 📰 Source : partner-feeds.20min.ch


Les mineurs arrêtés étaient en fait majeurs
Trois individus ont été interpellés dimanche, à Annemasse, (F) à bord d’un véhicule volé. Ils étaient soi-disant âgés de 16 et 17 ans. Ce n’était pas le cas.🕒 11:27 · 22 / 10 / 2025 | 📰 Source : partner-feeds.20min.ch


Un dossier XXL de 7000 pages pour le procès d'un trafiquant
Un homme est jugé pour trafic de drogue et de montres depuis lundi. Les avocats dénoncent la longueur «stratosphérique» du dossier.🕒 11:04 · 22 / 10 / 2025 | 📰 Source : partner-feeds.20min.ch


Une violente tempête va toucher la Suisse dès jeudi
La première tempête automnale frappera notre pays cette fin de semaine. Et elle sera puissante, avec des rafales à 120-150 km/h sur les crêtes du Jura et des Préalpes.🕒 08:09 · 22 / 10 / 2025 | 📰 Source : partner-feeds.20min.ch


Le feu rouge à 11 minutes d’attente fait réagir jusqu’à Paris
Un feu rouge à la sortie de Colombier, dans le canton de Neuchâtel, fait patienter les automobilistes plus de dix minutes. De quoi agacer les uns… et faire rire les autres, jusqu’à Paris, où Laurent Ruquier s’en est amusé dans son émission «Les Grosses Têtes». (chs)🕒 19:31 · 21 / 10 / 2025 | 📰 Source : partner-feeds.20min.ch


Il risque 14 ans de prison pour avoir tiré sur son voisin bruyant
Mardi, la procureure a requis la tentative d'assassinat pour un sexagénaire qui avait fait feu sur son voisin d'en face, en 2022, à Chavornay.🕒 19:23 · 21 / 10 / 2025 | 📰 Source : partner-feeds.20min.ch


Employée harcelée: la justice confirme la sanction de l'aéroport
La Cour a donné raison à une salariée de Cointrin virée après avoir dénoncé des propos sexistes et racistes à son encontre. Elle recevra une enveloppe de 100'000 francs.🕒 18:09 · 21 / 10 / 2025 | 📰 Source : partner-feeds.20min.ch


Un bus des TPG percuté par un train de marchandises
Un accident s’est produit lundi à un passage à niveau situé à Saint-Julien (F). Il n’y a aucun blessé à déplorer.🕒 15:25 · 21 / 10 / 2025 | 📰 Source : partner-feeds.20min.ch


Un rare canard américain observé à Neuchâtel
Espèce d'Amérique du Nord, le fuligule à tête noire barbote ces jours dans le port de Neuchâtel. Il a probablement été pris dans une tempête pour finir ici.🕒 13:43 · 21 / 10 / 2025 | 📰 Source : partner-feeds.20min.ch


Gare aux escroqueries liées à la vente de bois de chauffage
Les escrocs, qui repèrent parfois leurs victimes sur Facebook, réclament de l'argent aux intéressés, mais ne leur envoient jamais la marchandise.🕒 13:34 · 21 / 10 / 2025 | 📰 Source : partner-feeds.20min.ch


Petit changement à l'Exécutif après l’élection de Nicolas Walder
Le conseiller d’État fraîchement élu reprend le Département du territoire, moins l’Office de l’énergie et les SIG.🕒 12:38 · 21 / 10 / 2025 | 📰 Source : partner-feeds.20min.ch


Police des polices saisie après une intervention «musclée»
Au cours d’une interpellation devant un théâtre vendredi, un spectateur aurait été mis en joue et un comédien plaqué au sol et menotté.🕒 10:50 · 21 / 10 / 2025 | 📰 Source : partner-feeds.20min.ch


Un Vaudois impliqué dans le cambriolage de deux armureries
Des malfrats ont dérobé des armes et des munitions à Renens. D'autres ont tenté d'en faire autant au Mont-Sur-Lausanne. Neuf suspects ont été arrêtés, dont un Vaudois.🕒 10:45 · 21 / 10 / 2025 | 📰 Source : partner-feeds.20min.ch


Le séjour linguistique «chez l’habitant» vire au fiasco
Un jeune devait étudier à Malte avec EF. Le logement était insalubre et les hôtes absents.🕒 08:26 · 21 / 10 / 2025 | 📰 Source : partner-feeds.20min.ch


Les boulangers vaudois en guerre contre le pain à 99 centimes
Les artisans-boulangers du canton lancent une action pour rappeler que le pain artisanal n’est pas un produit d’appel et qu'il a un coût bien réel.🕒 08:07 · 21 / 10 / 2025 | 📰 Source : partner-feeds.20min.ch


Le trafic a été rétabli entre Lausanne et Yverdon
Une perturbation a interrompu le trafic entre Bussigny et Cossonay-Penthalaz. Plus aucun train ne circulait sur cet axe, mais le trafic a été rétabli vers 17h.🕒 07:00 · 21 / 10 / 2025 | 📰 Source : partner-feeds.20min.ch


Il tire sur son voisin trop bruyant: «J’ai pété les plombs»
À l'été 2022, un sexagénaire de Chavornay a fait feu à six reprises en direction de son voisin d'en face. Il est jugé ces jours pour tentative d'assassinat, notamment.🕒 06:04 · 21 / 10 / 2025 | 📰 Source : partner-feeds.20min.ch


Début d’incendie rapidement maîtrisé dans un appartement
L’alarme a été donnée lundi, en fin d'après-midi, un début d’incendie s’étant déclaré dans un appartement de la vieille ville de Saint-Ursanne.🕒 21:59 · 20 / 10 / 2025 | 📰 Source : partner-feeds.20min.ch


Trottinettes électriques et vélos bannis du centre de Carouge
Les deux-roues ne peuvent plus circuler dans la zone piétonne de la Cité sarde. Une mesure prise après des signalements.🕒 17:35 · 20 / 10 / 2025 | 📰 Source : partner-feeds.20min.ch


Genève aide les particuliers à installer des bornes électriques
Depuis jeudi, l'Etat propose un soutien pour l’achat de bornes individuelles dans les parkings collectifs, ainsi qu’une aide pour la création de bornes mutualisées.🕒 16:58 · 20 / 10 / 2025 | 📰 Source : partner-feeds.20min.ch


Suspendue dans le vide au Moléson, elle échappe de peu à la mort
Une grimpeuse a chuté sur la via ferrata de la montagne et s’est retrouvée suspendue la tête en bas dans le vide. La Rega a mené un sauvetage exigeant pour la sauver.🕒 15:47 · 20 / 10 / 2025 | 📰 Source : partner-feeds.20min.ch


Action contre le futur abattoir XXL de Micarna à Saint-Aubin
Des militants de la cause animale anonymes ont protesté tôt lundi dans le village à coup de banderoles pour dénoncer le méga-abattoir de volailles prévu.🕒 15:29 · 20 / 10 / 2025 | 📰 Source : partner-feeds.20min.ch


Près de la moitié des cadres RH sont des frontaliers
Selon les derniers chiffres franco-suisses, 45% des postes de responsable des ressources humaines sont occupés par des frontaliers.🕒 15:02 · 20 / 10 / 2025 | 📰 Source : partner-feeds.20min.ch


Condamné après avoir agressé le personnel de l'HFR
Après une première condamnation, un homme sous curatelle a pris cher, après avoir commis plusieurs agressions envers les employés de l'hôpital.🕒 12:13 · 20 / 10 / 2025 | 📰 Source : partner-feeds.20min.ch


Une sculpture antipolice retirée du LUFF
Un visiteur a été choqué par une œuvre du Lausanne Underground Film and Music Festival. La sculpture montrait un bidon d'essence se déverser sur un fourgon de police.🕒 12:07 · 20 / 10 / 2025 | 📰 Source : partner-feeds.20min.ch


Une famille intoxiquée au monoxyde de carbone
Un couple et ses enfants ont dû être pris en charge par les secours, samedi, à proximité de Genève.🕒 11:36 · 20 / 10 / 2025 | 📰 Source : partner-feeds.20min.ch


Cette course lausannoise cartonne même à l’étranger
La Vortex Race, née sur le campus de l’Université de Lausanne, séduit jusqu’à CNN et France 3. Une course en spirale, 3 km à gravir sur la rampe mythique du bâtiment du Vortex.🕒 10:12 · 20 / 10 / 2025 | 📰 Source : partner-feeds.20min.ch


Des centaines de personnes ont manifesté pour la Palestine
Les manifestants espèrent que l'ONU prendra des mesures afin que la responsabilité des multinationales dans la situation à Gaza soit reconnue et sanctionnée.🕒 18:47 · 19 / 10 / 2025 | 📰 Source : partner-feeds.20min.ch


Martial Courtet, critiqué et sans parti, reste dans la course
Les trois candidats sortants arrivent en tête du premier tour des élections au gouvernement jurassien ce dimanche. L'ex-centriste Martial Courtet se positionne troisième.🕒 17:44 · 19 / 10 / 2025 | 📰 Source : partner-feeds.20min.ch


Une femme perd la vie en tombant d'un tracteur
La passagère d'un véhicule agricole a lourdement chuté samedi matin à Farvagny-le-Grand. Elle est décédée sur place.🕒 15:03 · 19 / 10 / 2025 | 📰 Source : partner-feeds.20min.ch


Nicolas Walder est élu au Conseil d'État
Le Vert parvient à conserver le siège laissé vacant par Antonio Hodgers. Lionel Dugerdil ne remporte pas son pari de faire entrer l'UDC dans l'Exécutif genevois.🕒 12:49 · 19 / 10 / 2025 | 📰 Source : partner-feeds.20min.ch


Un véhicule en panne impliqué dans un carambolage sur l'A16
Un accident a eu lieu samedi après-midi sur l’A16 vers Bassecourt. Une voiture en panne a été percutée par deux véhicules. Aucun blessé grave n’est à déplorer.🕒 21:41 · 18 / 10 / 2025 | 📰 Source : partner-feeds.20min.ch


Octobre rose: les pompiers illuminent 60 sommets de Haute-Savoie
À l'aide de fumigènes roses, les sapeurs-pompiers vont faire un geste symbolisant la lutte contre le cancer du sein.🕒 19:05 · 18 / 10 / 2025 | 📰 Source : partner-feeds.20min.ch


Un automobiliste se tue en percutant un poids lourd à l'arrêt
Le conducteur âgé de 30 ans a traversé la voie de gauche et s'est encastré dans le camion garé sur le bord de la chaussée. Il est mort sur le coup.🕒 18:24 · 18 / 10 / 2025 | 📰 Source : partner-feeds.20min.ch


La Fondation Wilsdorf a acheté un hôtel pour les sans-abris
L'établissement situé aux Pâquis a été remis au Collectif d’associations pour l’urgence sociale (CausE) pour une durée de dix ans.🕒 16:59 · 18 / 10 / 2025 | 📰 Source : partner-feeds.20min.ch


Robbie Williams a perdu 13 millions dans la revente de sa villa
Il y a moins de cinq ans, le chanteur britannique avait acquis une propriété à Vandoeuvres pour 29 millions. Il l'a revendue 16 millions.🕒 16:28 · 18 / 10 / 2025 | 📰 Source : partner-feeds.20min.ch


Crise au CICR: 240 emplois supprimés à Genève
La Genève internationale est toujours sous pression. Rencontrant des difficultés financières, le Comité international de la Croix-Rouge coupe dans ses effectifs.🕒 16:03 · 18 / 10 / 2025 | 📰 Source : partner-feeds.20min.ch


Un carac géant présenté à Yverdon pour la bonne cause
Un carac rose XXL a été confectionné à Yverdon et partagé ce samedi avec la population dans le cadre du mois de lutte contre le cancer du sein.🕒 15:47 · 18 / 10 / 2025 | 📰 Source : partner-feeds.20min.ch


L'autoroute blanche a entamé sa révolution en matière de péages
Sur l'A40, c'est bientôt la fin des gares de péage. Les dispositifs appelés à les remplacer commencent à être installés. En 2027, les paiements se feront virtuellement.🕒 20:24 · 17 / 10 / 2025 | 📰 Source : partner-feeds.20min.ch


Coupable de mise en danger, le père prend 5 ans et demi de prison
Le quinquagénaire qui comparaissait cette semaine en correctionnelle a été condamné pour avoir enlevé ses enfants fin 2022 et mis en danger la vie des policiers en 2024.🕒 19:26 · 17 / 10 / 2025 | 📰 Source : partner-feeds.20min.ch


L'Uni pérennise les repas à 5 francs et le café à 1 franc
L'UNIGE a conclu deux nouveaux contrats avec des prestataires externes pour inscrire les offres avantageuses dans la durée. L'internalisation de la restauration attendra.🕒 16:22 · 17 / 10 / 2025 | 📰 Source : partner-feeds.20min.ch


Sexagénaire agressé en ville: plusieurs mineurs interpellés
Des jeunes impliqués dans l'agression d'un homme de 67 ans, mardi, ont été identifiés et entendus. Une procédure est en cours sous la direction de la juge des mineurs.🕒 15:11 · 17 / 10 / 2025 | 📰 Source : partner-feeds.20min.ch


L'ibis chauve qui a su trouver son chemin grâce à l'instinct
Un jeune oiseau d'une espèce menacée, a fait son premier voyage migratoire. Parti dimanche d'Allemagne, il a choisi d’instinct l’itinéraire qui survole Genève.🕒 14:26 · 17 / 10 / 2025 | 📰 Source : partner-feeds.20min.ch


Il fait taire son chien en public avec un dispositif interdit
Dimanche, sur une terrasse, un homme a calmé sa chienne avec une télécommande interdite par la loi. Le cas a été transmis au Service des affaires vétérinaires.🕒 12:54 · 17 / 10 / 2025 | 📰 Source : partner-feeds.20min.ch


Pollution du Léman: c'est confirmé, l'eau du robinet est potable
Le nouveau rapport d'expert demandé après la découverte d'une substance chimique dans l'eau de boisson lémanique est catégorique. Il n'y a pas de risque pour la santé.🕒 12:08 · 17 / 10 / 2025 | 📰 Source : partner-feeds.20min.ch


Le tram 17 à l'arrêt durant deux semaines côté français
Un chantier empêchera la desserte de ligne 17 à Annemasse (Haute-Savoie); et ce, jusqu'au 2 novembre.🕒 11:31 · 17 / 10 / 2025 | 📰 Source : partner-feeds.20min.ch


Un homme décède, écrasé par son propre véhicule
Alors qu'il était affairé dans un champ à la Claie-aux-Moines, un sexagénaire a eu un accident mortel de travail.🕒 11:02 · 17 / 10 / 2025 | 📰 Source : partner-feeds.20min.ch


Racisme dans la police: un agent disculpé, un autre a démissionné
Dans l'affaire des propos racistes et haineux qui ont circulé au sein de groupes WhatsApp, la procédure de licenciement est toujours en cours pour six policiers.🕒 10:40 · 17 / 10 / 2025 | 📰 Source : partner-feeds.20min.ch


L'EPFL invente une «pilule imprimante» qui soigne de l’intérieur
Des chercheurs de l’EPFL ont inventé la première bio-imprimante pouvant être avalée et guidée de l’extérieur pour réparer les parois du tube digestif.🕒 07:59 · 17 / 10 / 2025 | 📰 Source : partner-feeds.20min.ch


Ils injectent des neurones humains dans des ordinateurs
Des chercheurs suisses reproduisent des mini-cerveaux à l'aide de tissus humains qu'ils transforment en processeurs pour ordinateurs.🕒 07:27 · 17 / 10 / 2025 | 📰 Source : partner-feeds.20min.ch


Pour sauver son bébé, un couple doit réunir une somme colossale
Âgé de 13 mois, Erik souffre d'une maladie génétique extrêmement rare. Trois équipes de chercheurs travaillent sur son cas, mais c'est aux parents de les financer.🕒 06:12 · 17 / 10 / 2025 | 📰 Source : partner-feeds.20min.ch


«Ce n'était pas un week-end avec papa mais un enlèvement»
Le procureur a requis 6 ans contre un père accusé d'enlèvements et d'avoir failli tuer des policiers. La défense veut l'acquittement et une peine «empreinte d'humanité».🕒 21:45 · 16 / 10 / 2025 | 📰 Source : partner-feeds.20min.ch


Lancement d’un référendum contre le programme d’austérité
Le Parti socialiste lance un référendum contre le Programme d’assainissement des finances de l’Etat (PAFE). L’approbation du budget cantonal n'est pas remise en cause.🕒 19:59 · 16 / 10 / 2025 | 📰 Source : partner-feeds.20min.ch


L'État presse pour construire des immeubles plus écolos
Des modifications légales visent à réduire l'empreinte carbone des matériaux de construction, comme le béton. Les règles sur le solaire sont aussi renforcées.🕒 18:45 · 16 / 10 / 2025 | 📰 Source : partner-feeds.20min.ch


Un politicien neuchâtelois poursuivi pour viol
Une jeune femme affirme que le député libéral-radical Quentin Di Meo l'a agressée sexuellement en 2017. L'intéressé nie les faits.🕒 17:25 · 16 / 10 / 2025 | 📰 Source : partner-feeds.20min.ch


Un test d’un an pour réduire le trafic de transit aux Pâquis
La Ville va modifier la circulation dans le quartier situé sur la Rive droite. Des espaces piétons et végétalisés sont prévus.🕒 16:55 · 16 / 10 / 2025 | 📰 Source : partner-feeds.20min.ch


Route de Saint-Julien coupée durant plus d'une heure et demie
Les forces de l’ordre ont déployé un gros dispositif, jeudi après-midi, pour une intervention dans la sphère privée, à Plan-les-Ouates (GE).🕒 16:03 · 16 / 10 / 2025 | 📰 Source : partner-feeds.20min.ch


Les HUG transplantent deux valves sur le cœur d'un enfant
Un patient de 12 ans a subi une transplantation cardiaque partielle à l'hôpital cantonal. Une opération sans précédent en Europe.🕒 15:51 · 16 / 10 / 2025 | 📰 Source : partner-feeds.20min.ch


Spray contre les overdoses d'opioïdes disponible sans ordonnance
Dès le 1er novembre, l'accès au naloxone sera facilité en pharmacie. Genève prévoit de former des policiers et des intervenants sociaux à l'utilisation de cet antidote.🕒 15:41 · 16 / 10 / 2025 | 📰 Source : partner-feeds.20min.ch


Un bâtiment de 14 étages pour l’Université
L’édifice accueillera deux facultés et 3000 étudiants dès 2029 aux Vernets. La première pierre a été posée ce jeudi.🕒 14:41 · 16 / 10 / 2025 | 📰 Source : partner-feeds.20min.ch


Démission abrupte à la tête de l'AVIVO: l'ex-président s'explique
A la surprise générale, Ueli Leuenberger a posé son sac, lundi. Il invoque une rupture de confiance avec le bureau de l'association de défense des retraités.🕒 12:30 · 16 / 10 / 2025 | 📰 Source : partner-feeds.20min.ch


Sclérose en plaques: vers une réduction des effets secondaires
Des experts ont identifié des cellules immunitaires particulièrement impliquées dans la maladie, ouvrant la voie à des traitements plus ciblés et mieux tolérés.🕒 20:59 · 15 / 10 / 2025 | 📰 Source : partner-feeds.20min.ch


Un père devant les juges pour l'enlèvement de ses enfants
Fin 2022, le prévenu a récupéré son fils et sa fille à l'école et les a emmenés en France voisine. Il est aussi jugé pour tentative de meurtre envers des policiers.🕒 19:29 · 15 / 10 / 2025 | 📰 Source : partner-feeds.20min.ch


Collision en chaîne à Vernier, trafic perturbé
Un accident impliquant trois véhicules s’est produit mercredi après-midi à la route du Nant-d’Avril. Le secteur a été embouteillé.🕒 17:36 · 15 / 10 / 2025 | 📰 Source : partner-feeds.20min.ch


Près de 150 trottinettes électriques saisies durant l’été
La police municipale a relevé plus de 190 infractions entre fin mai et début octobre, lors d’une campagne contre les comportements dangereux en e-trott’.🕒 16:30 · 15 / 10 / 2025 | 📰 Source : partner-feeds.20min.ch


Les secours se rodent dans les tunnels du Léman Express
Un grand exercice pour tester les procédures de sauvetage dans le RER transfrontalier a eu lieu dans la nuit de mardi à mercredi. Un «succès», selon les autorités.🕒 15:40 · 15 / 10 / 2025 | 📰 Source : partner-feeds.20min.ch


Annulation du scrutin sur l'ouverture des magasins le dimanche
La votation sur les ouvertures dominicales n'aura pas lieu, comme prévu, le 30 novembre. En cause: des raisons légales, liées à une récente décision du Tribunal fédéral.🕒 15:35 · 15 / 10 / 2025 | 📰 Source : partner-feeds.20min.ch


Mains collées sur le pont du Mont-Blanc: une militante déboutée
Le Tribunal fédéral a rejeté le recours d’une membre de Renovate Switzerland. Celle-ci avait été condamnée, à la suite d’une action, en 2022.🕒 15:21 · 15 / 10 / 2025 | 📰 Source : partner-feeds.20min.ch


Propos racistes confirmés aux HUG mais «minimisés»
Un audit fait état de propos discriminatoires récurrents dans un secteur de l'hôpital cantonal. Mais des employés critiquent l'enquête, qui sous-évaluerait le problème.🕒 12:48 · 15 / 10 / 2025 | 📰 Source : partner-feeds.20min.ch


Deux personnes agressées en pleine rue: témoins recherchés
Deux personnes se sont fait agresser par plusieurs individus mardi soir à Bulle. Les agresseurs voulaient voler de l’argent à leurs victimes.🕒 12:00 · 15 / 10 / 2025 | 📰 Source : partner-feeds.20min.ch


Gros bouchon après une collision en chaîne
D'habitude déjà chargé, l'axe douane de Bardonnex-la Praille l'a été encore plus, mercredi matin, en raison d'une collision entre trois autos. Il n'y a pas eu de blessé.🕒 09:06 · 15 / 10 / 2025 | 📰 Source : partner-feeds.20min.ch


Des managers moins payés et forcés de passer le permis
Pour plus de proximité entre les conducteurs et ceux qui les encadrent, les Transports publics de la région lausannoise exigent que les managers prennent le volant.🕒 06:03 · 15 / 10 / 2025 | 📰 Source : partner-feeds.20min.ch


Malaise pour une enseigne coloniale au cœur de la Cité
Une représentation d'homme noir aux traits «exagérés» figure sur un bâtiment non loin de la Cathédrale. Aujourd'hui, son sort agite le voisinage et les autorités.🕒 20:23 · 14 / 10 / 2025 | 📰 Source : partner-feeds.20min.ch


Viol dans la maison des Schumacher? L'accusé n'est pas venu
Un pilote australien proche de Mick est accusé d’avoir violé une infirmière en 2019, dans la maison familiale des Schumacher, à Gland.🕒 20:11 · 14 / 10 / 2025 | 📰 Source : partner-feeds.20min.ch


L'eau de Daillens est de nouveau potable
Après une pollution à l'hydrocarbure identifiée vendredi, les habitants de la commune du Gros-de-Vaud peuvent de nouveau boire l'eau du robinet depuis mardi.🕒 18:54 · 14 / 10 / 2025 | 📰 Source : partner-feeds.20min.ch


Un mystérieux «semeur de clous» provoque des crevaisons en chaîne
Depuis un an, une rue de Publier (Haute-Savoie) est la cible des agissements d'un inconnu, qui jette des clous sur le bitume. Une quinzaine d'incidents ont été recensés.🕒 15:23 · 14 / 10 / 2025 | 📰 Source : partner-feeds.20min.ch


Trafic perturbé près des gares du Léman Express
En raison d’un exercice de sécurité, la circulation sera impactée autour des gares de Champel et de Chêne-Bourg, dès ce mardi soir.🕒 13:44 · 14 / 10 / 2025 | 📰 Source : partner-feeds.20min.ch


Démission surprise à la tête de l'AVIVO sur fond de tensions
Ueli Leuenberger a annoncé son départ immédiat de la présidence de l'association de défense des retraités, qui serait en proie à des difficultés financières.🕒 11:23 · 14 / 10 / 2025 | 📰 Source : partner-feeds.20min.ch


Villa en feu: les habitants arrivent à échapper aux flammes
Un incendie s’est déclaré dans une villa à Misery. Les habitants et leurs chiens ont pu évacuer à temps. L’habitation a été fortement endommagée.🕒 09:01 · 14 / 10 / 2025 | 📰 Source : partner-feeds.20min.ch


Le projet de budget 2026 a été rejeté d'emblée
Lundi soir, en plénière, la droite et Le Centre ont refusé l'entrée en matière sur le projet de budget. L'Exécutif devra revoir sa copie.🕒 20:37 · 13 / 10 / 2025 | 📰 Source : partner-feeds.20min.ch


Manger sainement, c’est bien, le faire régulièrement, c’est mieux
Ce n’est pas seulement ce que nous avalons qui influence notre santé intestinale, mais aussi la régularité avec laquelle nous mangeons sainement, selon l'EPFL.🕒 19:50 · 13 / 10 / 2025 | 📰 Source : partner-feeds.20min.ch


Des mouches par millions ont envahi les églises
Les insectes pourrissent la vie de lieux de culte jurassiens depuis la fin du mois de septembre. Une douzaine d'églises ont dû faire appel à des services de désinfection.🕒 18:35 · 13 / 10 / 2025 | 📰 Source : partner-feeds.20min.ch


Des pompiers luttent aux côtés des «combattantes» du cancer
Octobre rose mobilise les sapeurs volontaires de Collonge-Bellerive en faveur de la recherche contre le cancer du sein. Une soirée spéciale aura lieu vendredi.🕒 18:33 · 13 / 10 / 2025 | 📰 Source : partner-feeds.20min.ch


Le nombre de victimes recensées multiplié par quatre en huit ans
Les dispositifs vaudois et valaisan pour venir en aide aux victimes de traite portent leurs fruits. Le canton de Vaud a suivi 124 personnes en 2024, contre 30 en 2016.🕒 12:18 · 13 / 10 / 2025 | 📰 Source : partner-feeds.20min.ch


La justice déboute une policière blessée par une chute de branche
Sérieusement touchée par une branche qui lui est tombée dessus, une agente a accusé la Ville de Genève d'avoir négligé l'état de l'arbre. Non, a estimé la justice.🕒 12:06 · 13 / 10 / 2025 | 📰 Source : partner-feeds.20min.ch


La police sort le grand jeu devant plus de 8000 visiteurs
Petits et grands ont découvert la diversité des métiers au sein des forces de l'ordre, à l'occasion de la journée de la police, samedi à Palexpo.🕒 19:13 · 12 / 10 / 2025 | 📰 Source : partner-feeds.20min.ch


Accusée d'avoir tué sa grand-mère, elle aurait entendu des voix
La trentenaire poursuivie pour le meurtre de sa grand-mère en août avait déjà été condamnée pour des violences envers sa mère. Une expertise psychiatrique est en cours.🕒 15:24 · 12 / 10 / 2025 | 📰 Source : partner-feeds.20min.ch


Ils font sauter un bancomat juste à côté d'un groupe de fêtards
Un distributeur de billets a explosé dans la nuit de samedi à dimanche. Personne n’a été blessé. Deux individus à moto ont pris la fuite.🕒 12:57 · 12 / 10 / 2025 | 📰 Source : partner-feeds.20min.ch


Devenez lecteur reporter, envoyez-nous vos infos
Vous êtes témoin d'un événement riche en émotions? Transmettez-nous vos photos et vidéos via Whatsapp, Telegram, Signal ou Threema. Trois conseils pour faire de supers clichés et vidéos.🕒 06:01 · 08 / 02 / 2022 | 📰 Source : partner-feeds.20min.ch
EN DIRECT, guerre en Ukraine : après de nouvelles sanctions européennes, la Russie « se réserve le droit de répondre »
Avant un sommet à Bruxelles, l’UE a annoncé un 19e train de sanctions, visant les secteurs gazier et pétrolier russes, dans la foulée de celle des Etats-Unis qui ont sanctionné les compagnies Rosneft et Lukoil. Kiev a salué un « pas très important ».🕒 11:15 · 23 / 10 / 2025 | 📰 Source : www.lemonde.fr


Nouvelle-Calédonie : des blocages parlementaires inédits
Une motion de rejet préalable, déposée par le groupe macroniste pour contrer l’obstruction des députés « insoumis », a écourté les débats sur la proposition de loi organique reportant les élections provinciales. Le texte devrait être adopté en commission mixte paritaire.🕒 10:44 · 23 / 10 / 2025 | 📰 Source : www.lemonde.fr


A Besançon, un adolescent de 13 ans mis en examen pour le viol filmé d’un enfant de 9 ans
Un garçon de 8 ans, qui a imposé un rapport sexuel à la victime, est également impliqué dans ces faits mais n’est pas pénalement responsable en raison de son jeune âge, a précisé le parquet.🕒 10:41 · 23 / 10 / 2025 | 📰 Source : www.lemonde.fr


Airbus, Thales et l’italien Leonardo s’unissent dans les satellites pour contrer Starlink, l’entreprise d’Elon Musk
Les trois fabricants européens rapprochent leurs activités spatiales dans une société commune au chiffre d’affaires attendu de 6,5 milliards d’euros.🕒 10:32 · 23 / 10 / 2025 | 📰 Source : www.lemonde.fr


Retraites : les effets concrets d’une suspension de la réforme
La lettre rectificative au projet de budget de la Sécurité sociale pour 2026, qui devait être présentée jeudi 23 octobre en conseil des ministres, détaille le financement du report de l’âge légal de départ.🕒 10:28 · 23 / 10 / 2025 | 📰 Source : www.lemonde.fr
EN DIRECT, Gaza : l’Arabie saoudite condamne le vote au Parlement israélien pour l’examen de projets de loi visant à annexer la Cisjordanie
Le Parlement israélien s’est prononcé, mercredi, en faveur de l’examen de deux projets de loi visant à étendre la souveraineté israélienne en Cisjordanie, occupée depuis 1967. De quoi « menacer » la trêve, selon le secrétaire d’Etat américain, Marco Rubio, attendu jeudi dans l’Etat hébreu.🕒 10:14 · 23 / 10 / 2025 | 📰 Source : www.lemonde.fr


Les six ministres LR du gouvernement Lecornu, accusés de « se fondre dans le macronisme », ont été suspendus du parti
Face aux divisions et pressions internes, Bruno Retailleau, le président du parti, puis le bureau politique ont tranché mercredi pour une suspension de Rachida Dati, Annie Genevard, Vincent Jeanbrun et leurs trois autres collègues.🕒 10:06 · 23 / 10 / 2025 | 📰 Source : www.lemonde.fr
Des empreintes de dinosaures datant de 200 millions d’années découvertes en Lozère
Lors d’une mission éclair cet été sur le site encore inexploré du Castellas, dans le hameau de Saint-Laurent-de-Trèves, des paléontologues ont recensé plus d’une centaine de traces. Un parcours pédagogique devrait être aménagé sur place en 2027.🕒 09:31 · 23 / 10 / 2025 | 📰 Source : www.lemonde.fr

Injections illégales de Botox : nouveaux cas graves de botulisme en France
Les trois patients concernés présentent « des symptômes sévères de botulisme avec en particulier des difficultés respiratoires nécessitant une hospitalisation en soins intensifs », s’est alertée l’agence de sécurité du médicament.🕒 08:51 · 23 / 10 / 2025 | 📰 Source : www.lemonde.fr


En Birmanie, plus de 600 personnes fuient un centre d’arnaques en ligne vers la Thaïlande après un raid militaire
En Birmanie, des complexes tentaculaires, où des escrocs en ligne ciblent des étrangers avec des arnaques sentimentales et commerciales, ont prospéré le long de la frontière peu surveillée avec la Thaïlande pendant la guerre civile déclenchée par un coup d’Etat en février 2021.🕒 08:29 · 23 / 10 / 2025 | 📰 Source : www.lemonde.fr


Tempête Benjamin : 19 départements en vigilance orange pour vents violents, plus de 100 000 foyers privés d’électricité
De « fortes rafales » touchent « une bonne partie » de la France jeudi, selon Météo-France. Plus de 100 000 foyers étaient privés d’électricité jeudi matin sur l’ensemble du territoire, principalement en Nouvelle-Aquitaine, a fait savoir Enedis.🕒 07:28 · 23 / 10 / 2025 | 📰 Source : www.lemonde.fr


Victor Wembanyama démarre en trombe la saison NBA avec 40 points dès son premier match
Après huit mois d’absence en raison d’une thrombose veineuse, le joueur français de 21 ans a réalisé plusieurs actions spectaculaires et permis aux San Antonio Spurs de dominer facilement les Dallas Mavericks (125-92) en ouverture de leur saison.🕒 06:58 · 23 / 10 / 2025 | 📰 Source : www.lemonde.fr
Nicolas Sarkozy en prison à la Santé : la présence d’officiers armés pour assurer la sécurité de l’ancien chef de l’Etat suscite la colère de la pénitentiaire
Mercredi matin, le ministre de l’intérieur, Laurent Nuñez, a justifié la mesure par le « statut » du détenu et par les « menaces qui pèsent sur lui ». Les syndicats de surveillants dénoncent « une folie sécuritaire » et « une humiliation sans précédent ».🕒 06:30 · 23 / 10 / 2025 | 📰 Source : www.lemonde.fr


« Astérix en Lusitanie » : Fabcaro et Didier Conrad ressortent la potion magique
Les auteurs ont planché sur la quarante et unième aventure des héros de Goscinny et d’Uderzo, en reprenant les ingrédients qui ont fait le succès colossal de la série aux 400 millions d’albums vendus dans le monde.🕒 06:00 · 23 / 10 / 2025 | 📰 Source : www.lemonde.fr


Assurance-vie : le fonds en euros retrouve de l’attrait
Attendue cette année aux alentours de 2,6 %, comme en 2024, la performance moyenne des fonds en euros n’a rien de mirobolant. Elle a toutefois sensiblement gagné en compétitivité dans un contexte marqué par les baisses conjointes de l’inflation et des taux courts qui ont notamment repoussé le rendement du Livret A sous la barre des 2 %.🕒 06:00 · 23 / 10 / 2025 | 📰 Source : www.lemonde.fr
L’Asie du Sud-Est à l’épreuve de l’affrontement entre la Chine et les Etats-Unis
Face aux guerres commerciales de Donald Trump, les membres de l’Association des nations d’Asie du Sud-Est, créée en 1967, ont dû, faute de disposer d’institutions supranationales, négocier en ordre dispersé.🕒 06:00 · 23 / 10 / 2025 | 📰 Source : www.lemonde.fr


En Grèce, le succès des TikTokeurs roms cache des conditions de vie dramatiques
Les contributeurs de la plateforme issus de cette communauté font des millions de vues et affichent avec fierté leur culture. Mais derrière les écrans, les stéréotypes persistent.🕒 03:00 · 23 / 10 / 2025 | 📰 Source : www.lemonde.fr
Cambriolage du Louvre : « Ce vol n’est pas une fatalité », a admis Laurence des Cars devant les sénateurs
Trois jours après le spectaculaire vol de huit joyaux de la couronne de France, la présidente-directrice du musée a été auditionnée par la commission culture du Sénat pendant près de trois heures.🕒 21:42 · 22 / 10 / 2025 | 📰 Source : www.lemonde.fr
Initiations gratuites de sport - hiver 2025-2026
Envie de rester actif et active malgré le froid? La Ville de Genève relance ses initiations hivernales, des cours de sport gratuits et ouverts à tous et toutes dès 18 ans, du 26 octobre 2025 au 22 mars 2026. Ne laissez pas l’hiver vous ralentir… bougez avec nos cours hivernaux.🕒 14:53 · 16 / 10 / 2025 | 📰 Source : www.geneve.ch
Exposition "Mobilités. Enquêtes photographiques genevoises"
Le Centre de la photographie Genève et la Bibliothèque de Genève présentent l’exposition "Mobilités. Enquêtes photographiques genevoises" à l’Espace Ami Lullin du 31 octobre 2025 au 31 janvier 2026.🕒 11:36 · 16 / 10 / 2025 | 📰 Source : www.geneve.ch
TonUtopie: une sphère géante au Musée d’art et d’histoire
Une sphère gonflable s'est installée dans la cour du Musée d’art et d’histoire à Genève. Une création inédite de l’artiste allemand Hans-Walter Müller à explorer jusqu’au 31 août 2026.🕒 10:08 · 16 / 10 / 2025 | 📰 Source : www.geneve.ch
Une exposition sur les centenaires de Suisse aux Bastions
Du 16 octobre au 13 novembre 2025, la Ville de Genève accueille en avant-première nationale l’exposition "Welcome to your future - Centenaires de Suisse" au parc des Bastions. Une immersion dans la réalité des personnes âgées de 100 ans et plus vivant dans notre pays. Gratuit, sans inscription.🕒 09:30 · 15 / 10 / 2025 | 📰 Source : www.geneve.ch
Apaisement de la circulation aux Pâquis dans trois secteurs
Des modifications de la circulation sont actuellement mises en place dans trois secteurs aux Pâquis. Elles visent à réduire le trafic de transit, tout en proposant de nouveaux espaces piétons et récréatifs ainsi que des bacs de végétation.🕒 10:29 · 14 / 10 / 2025 | 📰 Source : www.geneve.ch
Les Fêtes des morts sous toutes leurs formes
D’Halloween aux visites de cimetières, en passant par la célébration du "Día de los Muertos" mexicain, plusieurs fêtes, animations et visites sont organisées à Genève, entre fin octobre et début novembre 2025. Retrouvez notre sélection!🕒 17:31 · 13 / 10 / 2025 | 📰 Source : www.geneve.ch
Visites guidées du cimetière de Petit-Saconnex
A l’occasion de la Toussaint, le Service des pompes funèbres, cimetières et crématoire propose au public de découvrir le cimetière du Petit-Saconnex et son histoire lors de visites guidées le samedi 25 et le dimanche 26 octobre 2025. Gratuit, sur inscription.🕒 16:11 · 13 / 10 / 2025 | 📰 Source : www.geneve.ch
Les expositions à voir à Genève cet automne
A travers leurs collections, les Musées de Genève couvrent une riche diversité de disciplines et domaines artistiques. Découvrez une sélection de leurs expositions temporaires à ne pas manquer cet automne.🕒 15:20 · 09 / 10 / 2025 | 📰 Source : www.geneve.ch
Nouvel exploitant pour l’Auberge de Jeunesse de Genève
Dès le 1er janvier 2026, une nouvelle page s’ouvre pour l’Auberge de Jeunesse de Genève. À sa tête, Alexandre Mathais, diplômé de l’École Hôtelière de Lausanne, a passé près de vingt ans à diriger des établissements à travers le monde.🕒 09:55 · 09 / 10 / 2025 | 📰 Source : www.geneve.ch
Conférence publique avec Sophie Lavaud et Jérémie Heitz: le destin croisé de deux aventuriers de l’extrême
Le jeudi 20 novembre, la Ville de Genève vous invite à une rencontre exceptionnelle avec deux figures majeures du monde de l’aventure et de la montagne: Sophie Lavaud, première Suissesse à avoir gravi les 14 sommets de plus de 8’000 mètres de la planète, et Jérémie Heitz, freerider et skieur de pente raide reconnu pour ses exploits à travers le monde.🕒 14:05 · 03 / 10 / 2025 | 📰 Source : www.geneve.ch
Votation populaire du 30 novembre 2025
Les citoyennes et citoyens genevois-es se prononcent le 30 novembre.🕒 15:54 · 02 / 10 / 2025 | 📰 Source : www.geneve.ch
Montrez-nous où vous respirez - Participez à l'enquête
Afin de garantir des espaces verts et extérieurs qui répondent au mieux aux besoins des Genevois et Genevoises, une enquête invite la population à s'exprimer sur ses habitudes! Les résultats du sondage contribueront au développement de tels espaces à Genève.🕒 15:54 · 26 / 08 / 2025 | 📰 Source : www.geneve.ch
Inauguration du pavillon de la gare routière - Place Dorcière
Ouvert depuis août, le pavillon rénové de la gare routière a été inauguré le jeudi 9 octobre 2025. Les voyageurs et voyageuses bénéficient désormais d’un équipement moderne, aux détails soignés.🕒 11:54 · 07 / 08 / 2025 | 📰 Source : www.geneve.ch
Balades urbaines à la découverte des quartiers: Pâquis et Saint-Jean/Charmilles à l'honneur
En octobre, partez à la rencontre de quartiers emblématiques de Genève à travers des balades guidées riches en découvertes culturelles, sociales et humaines. Deux rendez-vous sont prévus, ouverts à toutes et tous, pour explorer les ressources locales, tisser des liens et s’impliquer dans la vie de quartier des Pâquis et de Saint-Jean/Charmilles.🕒 16:41 · 08 / 10 / 2024 | 📰 Source : www.geneve.ch
Les filles prennent possession du skatepark de Plainpalais
Samedi 18 octobre, entre 12h et 18h, le Skatepark de Plainpalais accueillera le "Bad Witches Skateday", un événement qui fera la part belle aux skateuses, tout en étant ouvert aux garçons. En cas de pluie, il sera reporté au samedi 25 octobre.🕒 10:27 · 04 / 06 / 2024 | 📰 Source : www.geneve.ch
Festival de hip-hop "Occupe Pitoëff"
Le 20 septembre 2025 aura lieu une nouvelle édition du festival hip-hop organisé cette année avec le Service de la jeunesse au théâtre Pitoëff, à la salle communale de Plainpalais. Les billets sont en vente pour les concerts de Naza, Genezio et Mibsy!🕒 10:16 · 03 / 04 / 2023 | 📰 Source : www.geneve.ch
Repas entre seniors dans les Espaces de quartier
Du 25 novembre au 15 décembre 2025, des repas conviviaux sont organisés, dans six quartiers de la Ville, à l’intention du public aîné. L’occasion de faire de belles rencontres. Inscription préalable au 0800 44 77 00.🕒 12:22 · 17 / 11 / 2022 | 📰 Source : www.geneve.ch
Les vacances de patates à Genève: nos 30 idées
Que faire à Genève pendant les vacances d'octobre? Retrouvez notre sélection d’idées de sorties, pour les adultes comme pour les enfants, durant les vacances d’automne. De quoi faire le plein de bons moments à Genève du 18 au 26 octobre 2025!🕒 09:34 · 21 / 10 / 2021 | 📰 Source : www.geneve.ch
La Cérémonie du Souvenir rend hommage aux défunts à la Chapelle des Rois
Le Service des pompes funèbres, cimetières et crématoire organise une cérémonie laïque collective le samedi 1er et le dimanche 2 novembre 2025 à 16h30, à la Chapelle des Rois.🕒 17:36 · 28 / 10 / 2020 | 📰 Source : www.geneve.ch
Mes derniers souhaits: présentation publique à Cité Seniors et à l'Espace de quartier Plainpalais
Le Service social, en collaboration avec le Service des pompes funèbres, cimetières et crématoire propose, le jeudi 9 octobre et le vendredi 7 novembre 2025, une présentation gratuite du livret "Mes derniers souhaits" à Cité Seniors et à l'Espace de quartier de Plainpalais.🕒 15:41 · 19 / 02 / 2020 | 📰 Source : www.geneve.ch
Adjoint ou Adjointe de direction à 100%
🕒 02:05 · 23 / 10 / 2025 | 📰 Source : www.geneve.ch
Secrétaire de l'état civil à 80%
🕒 02:05 · 23 / 10 / 2025 | 📰 Source : www.geneve.ch
Responsable protection des données et transparence à 100%
🕒 02:05 · 23 / 10 / 2025 | 📰 Source : www.geneve.ch
Concierge professionnel polyvalent ou Concierge professionnelle polyvalente à 100%
🕒 02:05 · 23 / 10 / 2025 | 📰 Source : www.geneve.ch
Collaborateur ou Collaboratrice scientifique Herbier à 80-90%
🕒 02:05 · 23 / 10 / 2025 | 📰 Source : www.geneve.ch
Commandant / Chef d'unité adjoint ou Commandante / Cheffe d'unité adjointe à 100%
🕒 02:05 · 16 / 10 / 2025 | 📰 Source : www.geneve.ch
Gestionnaire de dossiers et facturation à 80%
🕒 02:05 · 16 / 10 / 2025 | 📰 Source : www.geneve.ch
Contrôleur ou Contrôleuse caméra de réseau assainissement à 100%
🕒 02:05 · 16 / 10 / 2025 | 📰 Source : www.geneve.ch
Fossoyeur ou Fossoyeuse à 100%
🕒 02:05 · 16 / 10 / 2025 | 📰 Source : www.geneve.ch
Archiviste à 50%
🕒 02:05 · 16 / 10 / 2025 | 📰 Source : www.geneve.ch
Techniscéniste à 90%
🕒 02:05 · 16 / 10 / 2025 | 📰 Source : www.geneve.ch
Adjoint ou Adjointe responsable 'prévention et gestion de crise' à 80%
🕒 02:05 · 16 / 10 / 2025 | 📰 Source : www.geneve.ch
Juriste à 80-100%
🕒 02:05 · 09 / 10 / 2025 | 📰 Source : www.geneve.ch
Ingénieurs ou Ingénieures en sécurité des bâtiments à 100%
🕒 02:05 · 09 / 10 / 2025 | 📰 Source : www.geneve.ch
Contremaître ou Contremaîtresse pépiniériste à 100%
🕒 02:05 · 09 / 10 / 2025 | 📰 Source : www.geneve.ch
Agent ou Agente en information documentaire à 60%
🕒 02:05 · 09 / 10 / 2025 | 📰 Source : www.geneve.ch
Chargé ou Chargée de missions à 50%
🕒 02:05 · 09 / 10 / 2025 | 📰 Source : www.geneve.ch
Gestionnaire de salaires à 80%
🕒 02:05 · 02 / 10 / 2025 | 📰 Source : www.geneve.ch
Gestionnaire administratif ou administrative en finance à 80%
🕒 02:05 · 02 / 10 / 2025 | 📰 Source : www.geneve.ch
Agent / Appointé ou Agente / Appointée à 100%
🕒 02:05 · 19 / 09 / 2025 | 📰 Source : www.geneve.ch
Drôles/Gags
Pages partagées
Codes HTML/MySQL/JAVA
Radios en Ligne